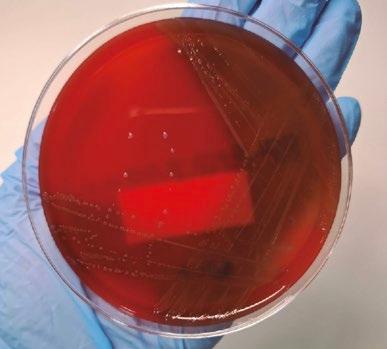
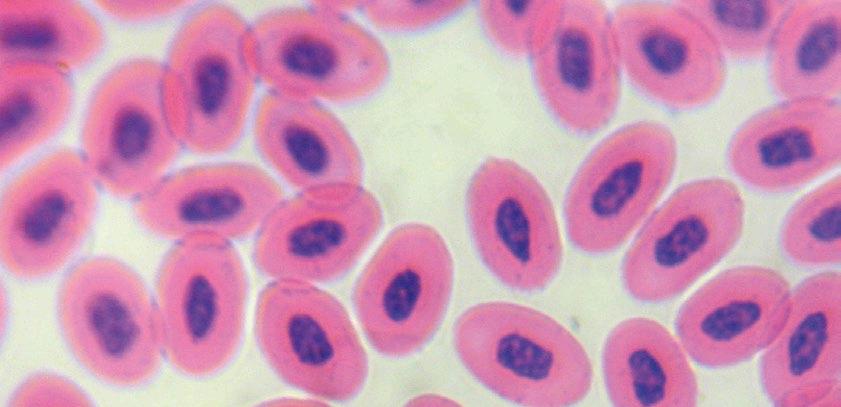

ACTUALIZACIÓN DE COSTES EN GRANJAS DE POLLOS







![]()







Granjas avícolas con historia: granja El Gallo Negro 06

José Antonio
Mendizabal Aizpuru
Catedrático de Producción
Animal. UPNA Académico Correspondiente de la RACVE
Energía solar y bombas de calor para la climatización de naves avícolas: resultados experimentales del proyecto RES4LIVE 20





A. Costantino1 , D. Tyris2, M. Goliomytis3 , G. Meramveliotakis4 , P. Bakalis
A. Gkountas5 , D. Manolakos
1Instituto de Ciencia Animal, Universitat Politècnica de València, València, España
2Department of Natural Resources Management and Agricultural Engineering, Agricultural University of Athens, Atenas, Grecia
3Department of Animal Science, Agricultural University of Athens, Atenas, Grecia
4ThermoDraft IKE, El Pireo, Grecia
5Psyctotherm, El Pireo, Grecia
28

Factores y estrategias que ayudan a mejorar el confort térmico de las aves
Humberto Marques Lipori MSc. Zootecnia
Actualización de costes en granjas de pollos 36

66
74
Manejo para lograr una persistencia óptima después del pico de puesta
Sara Cardona
Sales & Technical manager Aviagen
96

Factores que afectan a la calidad del pollito. Parte I
Equipo técnico de H&N International
80

Comparativa principales estirpes semipesadas de puesta
Bernardo González Aliseda
Formulación de piensos, gestión de proyectos e investigación en AVICULTURA.

104


Desde el procesado del pollo de engorde: ¡Preparándonos para alimentar nutritivamente al mundo!
Eduardo Cervantes López
Consultoría Internacional - Gerencia
Productiva e Innovadora en Procesamiento de Aves
Enterococcus cecorum: enfoque diagnóstico
Lorena Redrado Gómez y Silvia Anía Bartolomé
Exopol S.L. San Mateo de Gállego (Zaragoza) estatal de Carolina del Norte
92
Serproavi inaugura su nueva sede central en puente genil con ambiciosos planes de crecimiento
Equipo técnico de Serproavi
112
Enfermedad de newcastle: conociendo mejor al virus para tomar las mejores decisiones en el control. Parte I

Eliana Icochea D’Arrigo
Laboratorio de Patología Aviar
Facultad de Medicina Veterinaria, UNMSM-Lima-Perú






Concienciarse en serio sobre la bioseguridad en las granjas avícolas es fundamental para garantizar la salud de las aves, la seguridad alimentaria, y la sostenibilidad del negocio avícola.
Los principales motivos por los que es crucial tomar en serio la bioseguridad podemos establecerlos en:
1. Prevención de enfermedades. Se evita la entrada y propagación de enfermedades infecciosas como la Influenza aviar, Newcastle o Salmonelosis, entre otras. Las enfermedades pueden ocasionar altas tasas de mortalidad y pérdida de productividad.
2. Reducción de pérdidas económicas. Un brote puede provocar enormes pérdidas por muerte de animales, costos de tratamientos, cuarentenas o cierres temporales de las granjas y restricciones comerciales.
3. Protección de la salud pública. Algunas enfermedades aviares son zoonóticas, es decir, pueden transmitirse a los humanos (como ciertas cepas de influenza aviar o salmonella). Una buena bioseguridad reduce los riesgos de transmisión a consumidores.
4. Cumplimiento de normativas y exigencias del mercado. Los mercados nacionales e internacionales exigen estándares sanitarios rigurosos. La bioseguridad mejora la reputación del productor y facilita la exportación.
5. Evita el uso excesivo de antibióticos. Al prevenir enfermedades, se reduce la necesidad de usar medicamentos, ayudando a combatir la resistencia antimicrobiana.
6. Protección del personal y entorno. Reduce riesgos para los trabajadores y el medio ambiente (por ejemplo, menor contaminación de suelos o aguas por desechos infectados).
7. Sostenibilidad a largo plazo. Las prácticas de bioseguridad permiten mantener la producción constante y rentable a lo largo del tiempo.
Entonces ¿cómo es posible? que en el informe del Planes Nacionales de Vigilancia y control de Salmonella del año 2024 se detecten los siguientes porcentajes de granjas que incumplen con fallos excluyentes de bioseguridad entre otros, en los distintos sectores de producción:
Código Buenas
Documentado
Plan Desratización
Plan gestión
Vallado perimetral correcto
Es imprescindible en Bioseguridad no autoengañarnos en que lo hacemos muy bien y en que lo tenemos todo bien descrito y en documentos más o menos extensos. Los microorganismos patógenos están ahí afuera y en el momento que puedan encontrarán un fallo por donde entrar a las granjas.
Se ha producido la declaración de un foco de Influenza aviar en aves comerciales en España, tras varias declaraciones de detecciones del virus en aves salvajes. El virus está con nosotros y no se ha ido y dentro de unos meses volverán las aves migratorias con más carga vírica. Tampoco debemos olvidar la presencia del virus de Newcastle en varios países de Europa que han declarado oficialmente focos de la enfermedad.
Así que no queda otra, que apretar los dientes, repasar la documentación efectuada y comprobar que realmente se cumple en el campo y que no hay fallos.
Queremos agradecer públicamente a D. Gonzalo Arellano Peche, Presidente de la Asociación Española de Ciencia Avícola, el enorme esfuerzo realizado para llevar a cabo la actualización de los costos de granja en las crianzas de los pollos de engorde.
EDITOR
GRUPO DE COMUNICACIÓN AGRINEWS S.L.
PUBLICIDAD
Luis Carrasco +34 605 09 05 13 lc@agrinews.es
Félix Muñoz +34 618 18 00 16 felix@mediatarsis.com
DIRECCIÓN TÉCNICA
José Luis Valls
REDACCIÓN
Gerard Ponz
Daniela Morales F.X. Mora
COLABORADORES
José Ignacio Barragán
Luis Canela
Serafín García Freire
Edgar Oviedo Rondón
Juan Carlos López
Mike Czarick
Santiago Vega
Juan Carlos Abad
Eduardo Cervantes
Gonzalo González Mateos
Barcelona - España
Tel: +34 93 115 44 15 info@agrinews.es avinews.com
Precio de suscripción anual: España 36 € Extranjero 125 €
DIRIGIDA A VETERINARIOS Y TÉCNICOS
Depósito Legal aviNews
B11597-2013
ISSN (Revista impresa) 2696-8061
ISSN (Revista digital) 2696-807X
Revista bimestral
La dirección de la revista no se hace responsable de las opiniones de los autores. Todos los derechos reservados. Imágenes: Noun Project / Freepik/Dreamstime
José Antonio Mendizabal Aizpuru Catedrático de Producción Animal. UPNA Académico Correspondiente de la RACVE e-mail: jamendi@unavarra.es

La granja El Gallo Negro, establecida por Federico L. Vilches Bruzone en la Colonia Roldán, en Málaga (Fotos 1a, 1b), concretamente en el año 1877, fue otra de las primeras granjas avícolas de España.
Al igual que ocurría en la Granja Vella con su dueño, Luis Martí-Codolar, Federico Vilches fue un hombre de negocios que estableció en la Colonia Roldán una gran fábrica de cajas y estuches, llamada San Andrés.


Foto 1a: Vista General de la granja El Gallo Negro en la Colonia Roldán de Málaga
Esta empresa llegó a emplear a más de 400 trabajadores y surtía a toda España, exportando incluso sus productos a Francia y Estados Unidos.
Y, junto a esta empresa, Federico Vilches levantó sus gallineros.


El nombre con que fue bautizada la granja, El Gallo Negro, hacía referencia al tipo de gallinas que iba a criar y seleccionar Federico Vilches.

Esto lo sabemos porque, en 1886, va a imprimir un folleto publicitario dirigido a sus clientes (Foto 2), a modo de catálogo comercial de sus productos, en el que describe el tipo de gallina que está seleccionando, a la que denomina de raza Negra Castellana (Foto 3).

Foto 3. Imagen ilustrativa de las aves
Lo primero que llama la atención en el folleto publicitario es que las aves que representa gráficamente se corresponden con la raza Española Cara Blanca.


Dado que esta raza era cultivada fundamentalmente en Inglaterra y en otros países europeos, pero no en España, no creemos que la imagen que ilustraba su catálogo se correspondiera con el tipo de gallina que estaba seleccionando Federico Vilches.

El hecho de que ese mismo año de 1886 se publicara una nueva edición del libro sobre avicultura más célebre de la historia, The Illustrated Book of Poultry de Lewis Wright, que en su cubierta llevaba grabada la imagen de la Española Cara Blanca (Foto 4) podría haber influido en Federico Vilches para incorporar esta gallina como logo o icono de la granja El Gallo Negro.


En el interior del catálogo de Vilches nos encontraremos con la descripción morfológica y productiva de sus gallinas, que es la siguiente:

“Las aves cuya descripción hacemos en nuestro catálogo y circular de precios, son todas de pura casta y criadas con el esmero indispensable. Presentan plumaje negro tornasolado, cresta de sierra, recta en el gallo y caída en la gallina, cola recta, patas pizarra oscuro, lo mismo en uno que en otra. La gallina es buena ponedora de huevos blancos, de buen tamaño, y empieza la postura antes de los 6 meses. La postura regular de esta raza, es de 110 á 120 huevos en el primer año, y de 120 á 130 en el segundo”.

El caso es que, desgraciadamente, la descripción que realiza Vilches de las gallinas que cría no aclara el color de la cara de las mismas, cuestión que despejaría la pregunta de si el tipo de gallina que seleccionaba se aproximaba o no al de la Española Cara Blanca.
Foto 4. Portada del libro de Lewis Wright





DURABILIDAD, BIENESTAR Y MÁXIMA RECOGIDA PARA SU GRANJA

ROBUSTOS Y DURADEROS
Estructura reforzada con patas de acero inoxidable y tablero de contrachapado fenólico para una larga vida útil, incluso en condiciones exigentes.
BIENESTAR QUE SE NOTA
Diseño que evita corrientes de aire, expulsor articulado para un manejo suave y alfombrilla interior AstroTurf confortable y fácil de fijar.
MÁS SUPERFICIE, MÁS EFICIENCIA, MÁS HUEVOS
Mesa con variador de frecuencia y paro fotoeléctrico para un control total del proceso. Techo plano diseñado para que las gallinas puedan aprovechar más superficie de la nave.
PENSADOS PARA LIMPIAR FÁCIL
Materiales resistentes, zona del nido más grande y accesible y diseño que simplifica el mantenimiento diario.


De la aparición de este catálogo se dio cuenta en la revista El Naturalista, que dirigía el profesor veterinario de Barcelona Francisco d´Asís Darder y Llimona que insertó estas líneas en su número de enero de 1887.


“Hemos recibido un pequeño folleto sobre la Granja de Avicultura establecida y dirigida por su propietario don Federico L. Vilches, de Málaga; cuyo ejemplo deseamos que tenga muchos imitadores, para que, desarrollándose en nuestro país la cria de gallináceas, podamos emanciparnos de la importacion extranjera”.

Unos años más tarde, en 1895, Federico Vilches publicaría un pequeño tratado de avicultura que tituló: “Como pueden tenerse gallinas” (Foto 5).
En él se habla por primera vez de raza Castellana Negra (Foto 6) en lugar de raza Negra Castellana, como se venía llamando hasta entonces.

Ilustración de la raza Castellana Negra


Y también se aporta un primer patrón de la raza que se establece en los siguientes
“Plumage negro tornasolado, muy brillante, especialmente después de la muda.
Cresta de sierra, caida en la gallina y recta en el gallo.
Cola recta, variando la del gallo en las plumas del centro que son mucho más largas y caen en forma de arco.
Alas largas y bien cubiertas de plumas.
Patas pizarra oscuro y con cuatro dedos largos.
Pecho ancho y cuello grueso.
Pico algo corvo y muy fuerte.
Oreja blanca matizada.
Ojo muy vivo, redondo y la pupila negra azulada.
El pollo se distingue cuando pequeño por tener la pechuga blanca, quedando luego todo negro en la primera muda.
Los huevos son blancos y limpios, de tamaño mediano en la pollita y bastante grande en la gallina. El peso ordinario de 65 a 75 gramos.”
A pesar de la modificación en el nombre de la raza, Vilches mantiene el logo de su granja con esa pareja de gallo y gallina del tipo de la Española Cara Blanca.
El hecho de que en este primer patrón de la raza se especifique que la oreja ha de ser blanca matizada pero no haga referencia a las peculiaridades del color en la cara, hace suponer que esta sería de la coloración habitual, esto es, roja, como hemos conocido siempre a la Castellana Negra.
Cuando en 1899 tuvo lugar en Barcelona la primera exposición avícola propiamente dicha que se celebró en España, Federico Vilches acudió a ella como expositor y concursante con sus gallinas Castellana Negra, de tal manera que consiguió el primer premio en la sección de gallinas de esta raza.
Además de él, obtuvieron premios los avicultores catalanes Alejandro y José Pons, José Casasayas, J. Siljar de Palma de Mallorca y Manuel Cano de Madrid. Por tanto, la gallina Castellana Negra seleccionada y mejorada ya se iba extendiendo por las diferentes regiones españolas.



Casi a la vez que este logro exitoso, en el mes de diciembre de 1898 comenzó Federico Vilches a editar un boletín, al que da el nombre de su granja El Gallo Negro (Foto 7).
El objetivo del mismo fue dar información general acerca de las actividades más destacables de la avicultura española como exposiciones, nueva bibliografía, etc.; pero también dar a conocer los trabajos de cría y selección que se llevaban a cabo en la granja de su propiedad y anunciar sus productos. A este respecto, en el boletín nº 4 se informa que:

“Tenemos ya sacados unos 200 pollitos de los dos lotes de Gallinas con sus gallos que recibimos de Inglaterra en el mes de octubre de 1899 por vapor “Cecilia” de Liverpool y nada mejor podíamos haber esperado.
Dichos lotes proceden de uno de los mejores criadores dedicados a la Raza Castellana y que obtuvo primer premio en la Real Exposición de Avicultura del pasado año, habiendo vendido una pareja de la misma casta en catorce guineas (hoy cerca de Ptas. 500 de nuestra moneda).
Nuestro objeto ha sido cruzar y mejorar lo que tenemos, bien conocido hoy en toda España y aún en el extranjero. Nos proponemos sacar esta temporada de 500 a 600 pollitos, calculando poder seleccionar de 50 á 60 machos, de los que la mitad próximamente podremos ofrecer en venta desde Julio próximo. La postura de dichas gallinas es tan abundante, que aunque nos daban la seguridad de que así seria, nos tiene admirados y creemos haya podido influir algo el cambio de clima. Es en todos conceptos el buen tipo de la Gallina Negra Castellana”.
Iban, por tanto, muy bien las cosas para la granja El Gallo Negro y para el proceso de selección y mejora de la Castellana Negra.


Así se corroboraba también en otro de los números en el que, en la sección Correspondencia con los suscriptores, se recogen transacciones de gallinas Castellana Negra desde Málaga a avicultores de otras poblaciones de Andalucía, de Madrid (salían los pedidos a las 8 de la mañana y llegaban a las 6 de la mañana del día siguiente) e, incluso, de Londres.
Pero en diciembre de 1900 se produce un hecho inesperado para el devenir de la granja El Gallo Negro.
Por razones administrativas, el Gobierno Civil de Málaga suspendió la concesión que había hecho a F. Vilches en la Colonia Roldán y este se vio en la obligación de trasladar sus instalaciones.
Así lo describe a sus lectores y suscriptores en el boletín y señala con pena que:
“en virtud de ello ha resuelto ofrecer en venta:
1O. 2O. 3O. 4O.
La Granja, como se halla constituida.
Todo su material móvil
La existencia total de aves, y
Lotes de gallinas y gallos, incluso los reproductores traídos de Inglaterra en el año anterior, y los ya formados para el cruce de gallos hijos de aquellos con gallinas de esta Granja y viceversa.”
Este infortunio tuvo como consecuencia colateral la interrupción de la publicación del boletín avícola, con lo que carecemos de información precisa acerca de los hechos que se sucedieron tras determinar el “desahucio” de la granja avícola en la Colonia Roldán.
El caso es que en 1906 vemos anunciada la granja avícola La Castellana, situada ahora en el Valle de los Galanes, a unos 12 km de la localización anterior en la Colonia Roldán, manteniendo las oficinas en la misma localización de Marqués de Larios 7 y bajo la copropiedad de Vilches y Castañer (Foto 8).

publicitario de la granja La Castellana






Reforma de naves avícolas: modernización, eficiencia y rendimiento de avícolas: modernización, y rendimiento
Reforma de naves avícolas: modernización, eficiencia y rendimiento
Reforma de naves avícolas: modernización, eficiencia y rendimiento
En Comavic Group también transformamos instalaciones existentes en granjas modernas, equilibradas y preparadas para producir con las máximas garantías
En Comavic Group también transformamos instalaciones existentes en granjas modernas, equilibradas y preparadas para producir con las máximas garantías
Si tu nave necesita una actualización, analizamos cada sistema y te proponemos mejoras con tecnología probada, adaptada a tu tipo de producción.
Si tu nave necesita una actualización, analizamos cada sistema y te proponemos mejoras con tecnología probada, adaptada a tu tipo de producción
✅ Ventilación Munters Agriculture Hub : confort térmico, calidad del aire y control preciso
✅ Ventilación Munters Agriculture Hub : confort térmico, calidad del aire y control preciso
✅ Comederos VDL Agrotech y Giordano Global: alimentación eficiente, uniforme y sin desperdicio
✅ Comederos VDL Agrotech y Giordano Global: alimentación eficiente, uniforme y sin desperdicio
✅ Bebederos Impex Barneveld B V y Giordano Global: suministro constante, limpio y adaptado a cada etapa del lote
✅ Ponedero VDL Jansen y transporte de huevos FlexBelt: calidad del huevo y recolección fluida
✅ Bebederos Impex Barneveld B.V. y Giordano Global: suministro constante, limpio y adaptado a cada etapa del lote
✅ Ponedero VDL Jansen y transporte de huevos FlexBelt: calidad del huevo y recolección fluida
✅ Iluminación HATO Agricultural Lighting: estimulación óptima del comportamiento y consumo energético reducido
✅ Automatización y control climático TUFFIGO RAPIDEX: todo bajo control, todo más fácil
✅ Iluminación HATO Agricultural Lighting: estimulación óptima del comportamiento y consumo energético reducido
✅ Automatización y control climático TUFFIGO RAPIDEX: todo bajo control, todo más fácil
�� No se trata solo de cambiar equipos: se trata de repensar la nave para que trabaje mejor. Y ahí es donde sumamos valor.
�� No se trata solo de cambiar equipos: se trata de repensar la nave para que trabaje mejor Y ahí es donde sumamos valor



977 75 54 60
Esto hace suponer que, ante la situación sobrevenida, Federico Vilches se asoció con Mateo Andrés Castañer Vílchez, que era el propietario de gran parte de los terrenos que constituían el Valle de los Galanes, en la proximidad de la capital malagueña, y que ambos llegaron a un acuerdo para crear una nueva sociedad y trasladar la granja al Valle de los Galanes.
En este sentido, en 1906, anuncian nuevamente sus aves en forma de catálogo, manteniendo el logo original de la primitiva granja (Foto 9).


Así mismo, vemos que la granja se anuncia en la prensa nacional. Por ejemplo, en 1909 en el periódico Nuevo Mundo y en Heraldo


“Gallinas Castellanas negras, pura raza, extraordinaria ponedora, huevos para reproducción. Incubadoras prácticas, económicas. Pídase Catálogos á Vilches y Castañer, Málaga”.
Por tanto, la actividad avícola de F. Vilches y la selección y promoción de la Castellana Negra volvían a estar nuevamente en su punto álgido.
Esta situación duraría mientras vivió F. Vilches, esto es hasta aproximadamente 1917.

A la muerte de Federico Vilches se sabe que la granja avícola La Castellana fue adquirida por Federico Acosta Merino.
Este, dotado de grandes inquietudes comerciales, continuó con la granja avícola pero simultáneamente estableció una fábrica de frutos secos en el propio Valle de los Galanes y una fábrica de conservas de pescado en el cercano enclave de El Palo.
Parece ser que los nuevos negocios fueron floreciendo y el de la granja avícola quedó a un lado.
De esta manera, se cerraba una etapa de casi medio siglo de selección, mejora y difusión de la gallina Castellana Negra, que desde Málaga expandió la raza a toda la geografía nacional e incluso al extranjero.
Quedaría como recuerdo, hasta comienzos del siglo actual, la marca
La Castellana en las conservas de esta empresa del Valle de los Galanes y la hermosa imagen de un gallo y una gallina Castellana Negra que ilustraba sus etiquetas (Foto 10).
Principal bibliografía utilizada
Vilches F.L. (1895). Cómo pueden tenerse las gallinas. Tipografía de la Fábrica “San Andrés”. Colonia Roldán. Málaga.
Vilches F.L. (1899-1900). El Gallo Negro. Boletín de la Colonia Roldán (8 números). Málaga.

Etiqueta de las conservas La Castellana





A. Costantino1, D. Tyris2 , M. Goliomytis3, G. Meramveliotakis4, P. Bakalis5, A. Gkountas5, D. Manolakos2
1 Instituto de Ciencia Animal, Universitat Politècnica de València, València, España
2 Department of Natural Resources Management and Agricultural Engineering, Agricultural University of Athens, Atenas, Grecia
3 Department of Animal Science, Agricultural University of Athens, Atenas, Grecia
4 ThermoDraft IKE, El Pireo, Grecia
5 Psyctotherm, El Pireo, Grecia

Las ventajas de las bombas de calor en avicultura
Las bombas de calor representan una tecnología renovable con un gran potencial para su aplicación en avicultura, debido a su capacidad para aumentar la resiliencia de las instalaciones frente a las cada vez más frecuentes olas de calor.
Este potencial se debe a que, además de proporcionar calefacción, también pueden ofrecer refrigeración mecánica, una función clave para garantizar el bienestar de las aves en condiciones climáticas extremas.
Una bomba de calor es una máquina térmica capaz de transferir calor desde una fuente a baja temperatura hacia otra a mayor temperatura, mediante un ciclo de refrigeración que, generalmente, se basa en el trabajo mecánico de un compresor [1] .

Gracias a este principio, también es posible aprovechar el calor del ambiente exterior, contenido en el aire (aerotermia) o en el suelo (geotermia), como fuente térmica para calefactar el interior de la nave, lo que convierte a la bomba de calor en una tecnología basada en energías renovables [2]
A pesar de estas ventajas, el uso de bombas de calor en el sector avícola, y ganadero en general, sigue siendo muy limitado y existe una escasez de información sobre su rendimiento real, así como sobre su integración con sistemas fotovoltaicos.
La experimentación se llevó a cabo en la nave experimental de gallinas ponedoras de la Universidad de Agricultura de Atenas (Grecia), un pequeño espacio cerrado de 45 m² con jaulas enriquecidas, donde se alojan aproximadamente 330 gallinas ponedoras.
El sistema de climatización se basa en una bomba de calor aerotérmica con potencia frigorífica nominal de 10 kW, que está equipada de un compresor de tornillo controlado por un variador de frecuencia, dos intercambiadores de calor y un dry-cooler para disipar el calor residual.
Los componentes principales del sistema se ilustran en la Figura 1. El sistema incluye también dos ventiladores, uno para la impulsión del aire desde la bomba de calor al interior de la nave y otro para expulsar el aire desde el interior hacia el exterior.
Con el objetivo de contribuir al desarrollo de soluciones energéticas más sostenibles para la ganadería, en el marco del proyecto Horizon 2020
RES4LIVE [3] se ha desarrollado la experimentación, que se describe a continuación, centrada en el análisis del rendimiento conjunto de un sistema de bomba de calor y paneles fotovoltaicos en un caso de estudio real.


Figura 1 – Fotos del caso de estudio experimental: a) vista exterior del caso de estudio con la unidad principal de la bomba de calor (derecha) y el dry-cooler (izquierda); b) detalle de la unidad principal de la bomba de calor con el compresor y el intercambiador de calor; c) interior del caso de estudio con conductos para la entrada (beige) y salida (plateado) del aire.

La nave cuenta también con un sistema fotovoltaico de 9 kW de potencia pico, configurado para autoconsumo y vertido del excedente a red.
Para el análisis, el caso de estudio se instrumentó con sensores para el seguimiento del funcionamiento de la bomba de calor, las condiciones ambientales internas y el consumo energético.
Los resultados se presentan a continuación para un mes de verano y uno de invierno de 2023. Una panorámica más detallada sobre los resultados y la actividad llevada a cabo se puede encontrar en una publicación científica relacionada a esta actividad experimental [4]
A pesar de que el verano de 2023 fue uno de los más calurosos de los últimos años en Grecia, la bomba de calor reguló eficazmente la temperatura interior (ti).
La Figura 2 muestra los resultados correspondientes al período del 20 al 30 de julio de 2023. El sistema se programó para mantener la ti dentro de una banda de regulación de 25±2 °C (área verde en la figura), activándose en modo refrigeración al superar los 27 °C y desactivándose al descender por debajo de 23 °C.
Como se observa en la gráfica, la bomba de calor mantuvo la ti en la banda de regulación durante la mayor parte del periodo. Incluso durante las olas de calor, con temperaturas exteriores (te) de hasta 46 °C, la ti no superó los 30 °C, gracias a la operación prácticamente continua de la bomba de calor.
La eficiencia energética de la bomba de calor se mide a través del coeficiente de rendimiento (COP), que mide la relación entre la energía térmica transferida (en este caso desde el interior de la nave hacia el exterior, para enfriar el ambiente interior) y la energía eléctrica consumida.
Durante el periodo analizado, la bomba de calor operó de manera bastante energéticamente eficiente, puesto que el COP mantuvo un valor medio de 2.42 durante el periodo analizado.

Temperatura aire interior
Temperatura aire exterior
Temperatura de set point
Banda de regulación COP (Refrigeración)
Figura 2 - Evolución de la temperatura interior, exterior y del coeficiente de rendimiento (COP) para refrigeración de la bomba de calor entre el 20 y 30 de julio de 2023.
10 Dic 00:00 12 Dic 00:00 14 Dic 00:00
Temperatura aire interior
Temperatura aire exterior Tiempo
16 Dic 00:00 18 Dic 00:00 20 Dic
Temperatura de set point
Banda de regulación
COP (Refrigeración)
Figura 3 - Evolución de la temperatura interior, exterior y del coeficiente de rendimiento (COP) para calefacción de la bomba de calor entre el 10 y 20 de diciembre de 2023.
Durante diciembre, la bomba de calor operó en modo calefacción dentro de una banda de regulación de 19,5 ± 1,5 °C, logrando mantener eficazmente la ti en la banda, incluso cuando la t e descendió hasta los 3 °C.
Sin embargo, se observaron fluctuaciones en la ti , visibles en la Figura 3, provocadas por el funcionamiento intermitente del sistema: cuando la bomba de calor se activa (ti = 18 °C), la ti sube rápidamente hasta el límite superior de la banda (21 °C), momento en que la bomba de calor se desactiva. Dados los bajos valores de t e, la ti volvía a descender por debajo de los 18 °C, reactivando la bomba de calor.

La bomba de calor operó de manera muy eficiente desde un punto de vista energético, puesto que su rendimiento (COP) para calefacción tuvo un valor medio de 3,65 durante el período analizado.
El sistema permitió mantener también una buena calidad del aire interior, con concentraciones de CO₂ por debajo de los 1.500 ppm.
No obstante, a nivel cualitativo se observó una elevada acumulación de polvo.
Aunque se trate de una problemática habitual en instalaciones avícolas, en este caso parece más evidente por la configuración de las entradas y salidas de aire, que dificulta una adecuada expulsión del material particulado.

Como visto anteriormente, la bomba de calor se demostró una solución efectiva para mantener temperaturas interiores adecuadas en verano e invierno.
Sin embargo, su principal problema es el elevado consumo energético: el sistema consumió 4.032 kWh de energía eléctrica durante el mes de verano analizado y 2.390 kWh durante el mes de invierno, como reportado en la Tabla 1
Un sistema eficiente desde un punto de vista energético tendría que caracterizarse por una elevada autosuficiencia y un elevado autoconsumo. En ambos períodos, la autosuficiencia del sistema analizado fue alrededor del 20%.
El autoconsumo fue mayor en verano, puesto que casi toda la energía fotovoltaica se usó para cubrir la demanda energética de refrigeración.
En invierno, el menor consumo llevó a exportar parte de la energía fotovoltaica a la red, reduciendo el autoconsumo al 86 %.
Estos valores evidencian la necesidad de integrar la bomba de calor con el sistema fotovoltaico instalado, cuya producción para ambos periodos se resume en la Tabla 1.
La integración se evaluó mediante las métricas de autosuficiencia energética y el autoconsumo.
La autosuficiencia indica el porcentaje de las necesidades energéticas de la nave avícola que es cubierto por la generación in situ.
El autoconsumo indica el porcentaje de energía fotovoltaica que es usada directamente in situ y no vertida a la red.
Los datos de autosuficiencia y autoconsumo presentados en la Tabla 1 sugerirían la posibilidad de incrementar la potencia pico instalada.
Esto se debe al hecho que el sistema puede incrementar su autosuficiencia que, actualmente, es relativamente baja y tiene margen para mantener un autoconsumo elevado, puesto que actualmente está muy cerca del 100%, sobre todo en el periodo estivo.
Tabla 1 – Principales datos energéticos del sistema durante el periodo de verano (20 de julio – 19 de agosto de 2023) e invierno (1 – 30 de diciembre de 2023).


Sin embargo, el aumento de la potencia pico instalada es una opción que requiere un análisis cuidadoso, debido a posibles desfases entre la demanda energética y la disponibilidad de energía solar.
En la Figura 4 se muestran las tendencias de consumo eléctrico y generación fotovoltaica para una semana de verano y una de invierno.
En verano, la demanda energética es elevada (alrededor de 6 kW) y constante día y noche por la continua activación del compresor de la bomba de calor.
En invierno, la demanda suele ser menor (alrededor de 3 kW), pero con picos de hasta 8 kW por la tarde.
En consecuencia, un aumento de la potencia pico del sistema podría mejorar la autosuficiencia en ambos periodos, manteniendo elevado el autoconsumo.
No obstante, el desfase entre oferta y demanda en invierno y la carga nocturna constante en verano, sugieren evaluar la conveniencia de un sistema
Potenca Eléctrica [kW]
Condiciones de verano
00:00 10 5 0 00:00 00:00 00:00 00:00 00:00 Jul 20, 2023 - Jul 25, 2023 00:00
Condiciones de invierno
Potenca Eléctrica [kW]
00:00 10 5 0 00:00 00:00
Potencia consumida Potencia generada 00:00 00:00 00:00 Dic 01, 2023 - Dic 06, 2023 00:00
Figura 4 – Consumo de potencia eléctrica y generación de potencia de fotovoltaico durante una semana indicativa en verano (a) e invierno (b).


Una alternativa prometedora para mejorar el sistema, con potencial para nuevas investigaciones y oportunidades comerciales, es la implementación
Este consiste en alternar la refrigeración mecánica mediante bomba de calor con la ventilación mecánica, aprovechando el aire exterior durante la noche o en períodos de menor demanda de refrigeración.
Esta estrategia ofrece una doble ventaja.
En primer lugar, permite que la bomba de calor opere principalmente en las horas pico de demanda de refrigeración, que coinciden con los picos de radiación solar, lo que facilita cubrir gran parte de la carga de refrigeración con energía fotovoltaica.
En segundo lugar, al emplear ventilación mecánica en las horas nocturnas, se reduce el consumo energético y minimiza el desfase entre generación y demanda energética.
El sistema analizado se presenta como una solución prometedora para el sector avícola, al ofrecer un control climático eficaz incluso durante olas de calor y una elevada eficiencia energética.
A diferencia de los sistemas convencionales, como los paneles evaporativos, este sistema permite reducir la temperatura del aire interior sin incrementar la humedad relativa.
Esta característica representa una ventaja adicional comparado con los sistemas convencionales, ya que no solo implica un ahorro significativo de agua potable, sino que también hace este sistema apto para climas húmedos, donde los sistemas de enfriamiento evaporativo resultan poco eficaces.

Además, el sistema resulta específicamente adecuado para naves donde, por razones de bioseguridad, se requiere minimizar el caudal de ventilación en entrada se emplean sistemas de filtración, como ocurre en naves con elevado valor genético.
La principal desventaja actual del sistema analizado es el coste, puesto que requiere una inversión inicial considerable y puede suponer costes operativos y de mantenimientos relevantes.
En cuanto a los pasos futuros, las siguientes investigaciones apuntan a abordar varios aspectos claves antes de aplicar este sistema experimental a una granja comercial.
En primer lugar, resulta necesario optimizar la potencia pico del sistema fotovoltaico, para reducir la dependencia de la red eléctrica.
En segundo lugar, es fundamental analizar la configuración de las entradas y salidas de aire para minimizar la acumulación de polvo en el ambiente interior.
Por último, será necesario profundizar el desarrollo del enfoque híbrido mencionado anteriormente, con el objetivo de reducir el consumo energético y mejorar la integración con la generación fotovoltaica.
Energía solar y bombas de calor para la climatización de naves avícolas: resultados experimentales del proyecto RES4LIVE DESCÁRGALO EN PDF
Agradecimientos
Este estudio se desarrolló en el marco del proyecto RES4LIVE, que recibió financiación del Programa de Investigación e Innovación Horizonte 2020 de la Unión Europea, bajo el acuerdo de subvención nº 101000785. Andrea Costantino contó con el apoyo de la ayuda JDC2022-049782-I, financiada por el MICIU/AEI/10.13039/501100011033 y por la Unión Europea a través de NextGenerationEU/PRTR.





Humberto Marques Lipori MSc. Zootecnia
Entre los pilares de la cadena productiva del sector avícola, el ambiente es un factor importante que ha avanzado, debido a mejores instalaciones, equipos más eficientes, tecnologías que nos brindan datos rápidos y cómo gestionar los diferentes modos y así favorecer el confort térmico de las aves.




Las aves son animales homeotérmicos y, por tanto, dependen de la temperatura del ambiente para mantener su temperatura corporal en una media de 40,6°C.
En los primeros días de vida, el mayor intercambio de calor de las aves se produce a través de la conducción, que es el intercambio de calor entre el ave y la cama. Para que este intercambio de calor sea nulo, la cama necesita estar a una temperatura media de 30-32°C. De ahí la importancia de precalentar la nave. Considerando además que en la fase inicial de las aves el sistema termorregulador aún no está completamente formado.
Considerando los principales tipos de calentadores (hornos, campanas de gas, eléctricos, etc.), antes de adquirir un sistema de calefacción es necesario analizar todas las variables y evaluar ítem por ítem, entre ellas las principales son:
Eficiencia del calentador;
Vida útil del equipo;
Depreciación;
Mantenimiento;
Horas de trabajo para operar;
Costo de mano de obra según el tipo de calentador;
Si estas aves pasan por desafíos de temperatura, se produce una caída en el rendimiento en la que se altera su metabolismo.
Cuando la temperatura en la nave es inferior a la ideal para las aves, gran parte de los nutrientes del alimento balanceado que se utilizarían para el crecimiento serán desviados para mantener su regulación térmica.
Tenemos que tener en cuenta que en promedio, el 80% de los nutrientes que ingieren los pollitos están destinados al crecimiento y el otro 20% al metabolismo basal.
Los pollitos tienen un potencial muy grande de ganancia de peso en los primeros días de vida, alcanzando 4,6 veces su peso inicial en 7 días.
De esta manera, todos y cada uno de los desafíos que enfrentan las aves perjudicarán esta relación de ganancia de peso.
Costo de energía;
Seguridad del trabajador;
Asistencia técnica del equipo;
Disponibilidad de materias primas en la región;
Costo medio/lote de materia prima.
Por otro lado, si estas aves experimentan estrés térmico por calor consumirán más agua y menos alimento debido al aumento de la temperatura corporal, y en consecuencia a un aumento en la velocidad de paso del alimento, reduciendo la absorción de nutrientes.
Además, las aves en condiciones de temperatura elevadas intercambian calor mediante evaporación, un intercambio latente que consume mucha energía corporal.




Es extremadamente importante controlar el ambiente en que se encuentran las aves, ya que los mecanismos biológicos de intercambio de calor de las aves son poco eficientes.
Por tanto, cuanto más controlemos la temperatura y todos los factores que intervienen en el ambiente dentro de la nave, mejor será el rendimiento, ya que el ave en una zona de confort térmico es capaz de expresar eficientemente su potencial genético, logrando buenos resultados zootécnicos y, en consecuencia, económicos para el productor y la agroindustria.
En general, las naves han tenido un gran avance en términos de:
Ventilación;
Eficiencia de los calentadores,
Sellado;
Dimensionamiento.
Por otro lado, pocas granjas avícolas han invertido en aislamiento térmico. En cuanto al aislamiento térmico, la nave tendrá menor interferencia de la temperatura externa a la parte interna,
de esta forma, la nave se convierte en una “botella térmica”, si colocas algo frío o caliente en su interior mantendrá por más tiempo la temperatura en la que se colocó inicialmente.
Con esto, la nave mantendrá una mejor relación de temperatura ideal para las aves, por supuesto siempre observando su comportamiento, ya que este es el mejor “termómetro” para evaluar si las aves se encuentran en confort térmico.
En cuanto al sellado y aislamiento térmico, además de poder beneficiarse de un mejor ambiente para las aves, ayudará a reducir los costos de calefacción o enfriamiento y aumentar la vida útil de los equipos, es decir, toda entrada falsa de aire y menor aislamiento térmico es un costo adicional en la producción.
De hecho, cuando hablamos de ambiente, necesitamos analizar el conjunto, la parte estructural, la eficiencia de los equipos, el mantenimiento, la materia prima utilizada como calefacción y, lo más importante, cómo operar todos estos equipos y programación para satisfacer el confort térmico de las aves.









ESPESORES : 10cm y 15 cm
ALTURAS: 100cm , 150cm , 180cm y 200cm




INFORMACIÓN: OFICINAS: 938 29 04 20



Es importante reforzar este último ítem, tener una buena nave no garantiza buenos resultados zootécnicos, pero traerá menos desafíos ambientales, ya que bien gestionada la nave permite extraer lo mejor que este proporciona.
Los paneles isotérmicos, disponibles en el mercado, son muy eficientes, además de contribuir a un óptimo sellado y a una mayor vida útil de la naven en comparación con aquellos con cortinas a los lados.
Otro material disponible es la lana de vidrio o lana de roca, que se coloca sobre el revestimiento de la nave, donde tiene un gran potencial para ayudar a mantener la temperatura interna, ya sea al calentar o al enfriar.
Cuando está en periodo de calefacción, parte de esta calefacción sube y se disipa entre el revestimiento y el techo (ático), perdiéndose esta calefacción.
Además, durante las épocas calurosas del año, se forma un colchón de aire en el ático, donde este material aislante también reduce esta interferencia de temperatura dentro de la nave, considerando también que el ático es la parte más calurosa de la nave.

Aún teniendo en cuenta la calefacción, las naves que poseen inlets (entradas de aire) son muy eficientes, siempre y cuando se utilicen cuando sea necesario y correctamente, lo cual no es tarea fácil.
Es necesario mantener una buena dinámica del aire y una correcta distribución de la ventilación, esto también ayudará con la calidad de la cama.
Para lograr esto, es fundamental tener una buena relación entre el número de inlets con el número de extractores, una presión estática acorde con el ancho de la nave y la correcta apertura de las entradas, de lo contrario esto podría tener efectos negativos importantes en el desempeño del lote.
Considerando todos estos puntos mencionados anteriormente, igualmente importante es la calidad de la cama, que está directamente relacionada con la salud, pero también es uno de los puntos clave para mantener una buena temperatura dentro de la nave.
El porqué de la calidad de la cama, es que esta es uno de los factores que interfiere directamente en la ventilación mínima.
Cuanto mayor es la humedad en la cama, mayor es la producción de amoníaco, que es un gas muy nocivo para las aves, y para eliminar este amoníaco de la nave es necesario ventilarlo más. En consecuencia, esto hará aún más difícil calentar la nave.

Por eso es importante tratar bien la cama en el intervalo, una cama seca y de calidad no sólo reduce la cantidad de patógenos, sino que también reduce la formación de amoníaco.




Esto también dependerá de los días de intervalo que son fundamentales para un buen manejo de la cama.
A la luz de lo anterior, sabemos que casos de inviernos severos y camas húmedas plantean grandes desafíos para mantener la temperatura y la calidad del aire.
Los pollitos no toleran los rangos elevados de temperatura, por ejemplo, durante la tarde alcanza un promedio de 33°C y durante la noche baja a 28°C, o dependiendo de la situación, llega a 24°C o menos, lo que resultará en pérdidas importantes en el rendimiento e incluso alta mortalidad.

Figura 1. La humedad en la cama interfiere con la ventilación de la nave.
De todas formas, en casos extremos de temperatura exterior muy baja y alto nivel de amoníaco en el interior de la nave, entre elegir calentar y cumplir con la calidad del priorizar la buena calidad del aire.


Es menos grave tener una buena calidad del aire con una temperatura ligeramente por debajo de la ideal, que amortiguar y tener una gran producción de amoníaco dentro de la nave para intentar alcanzar una mejor temperatura.
El amoníaco causa muchos daños al rendimiento y a la salud.
Dependiendo de la cantidad y tiempo que esta ave esté expuesta al amoníaco, puede provocar ceguera, pero antes de eso, el amoníaco causa problemas importantes como:
Inmunosupresión;
Reduce el consumo de agua y alimento;

Provoca problemas respiratorios;
Sobrecarga la energía del cuerpo;
Disminuye la ganancia de peso y,
Peor conversión alimenticia.
Otro punto de atención son los crecientes desafíos que plantea la aerosaculitis; cuanto mayor sea la exposición de estas aves a malas condiciones, más empeorará este desafío.
Factores y estrategias que ayudan a mejorar el confort térmico de las aves.
DESCÁRGALO EN PDF
Cada día surgen nuevas tecnologías y estructuras que permiten un mayor control del ambiente en la producción de pollos de engorde.
Sin embargo, las mejores estructuras y tecnologías no garantizan buenos resultados zootécnicos, es necesario:
Buena gestión;
Interpretación de datos y hechos;
Compromiso y conocimiento impulsando estos nuevos modos y tecnologías.
Para extraer lo mejor que proporcionan, maximizando así la producción de forma sostenible y reduciendo los costos de producción.



Gonzalo Arellano Peche Consultor Avícola Presidente de la Asociación Española de Ciencia Avícola

En junio de 2019 presentamos la última actualización de costes de producción en granjas de pollos para carne.
Ahora, 6 años después, presento esta nueva actualización de costes con importantes variaciones respecto de la anterior.
En estos años han ocurrido hechos históricos sin precedentes que han influenciado el devenir actual de la avicultura de carne a nivel mundial y de forma particular en nuestro país, España, como son la pandemia provocada por la COVID-19 y la guerra de Ucrania, ambas de forma global, y el aumento de la población y del consumo particularmente en España.
Antes de comenzar a desglosar las distintas partidas que componen el coste de producción en las granjas de pollos, haremos un pequeño repaso de las condiciones sectoriales actuales que también dan lugar a los pagos a granja, con los cuales conformaremos la viabilidad actual de las granjas, confrontando los cobros con los gastos habidos durante la crianza de pollos.
En cuanto a la situación actual del Sector de la Avicultura de Carne en España analizaremos el número de granjas avícolas dedicadas a la actividad de cebo de pollos para carne y su variación a lo largo de los últimos años, así como a la producción anual de pollos que llegan a las plantas de procesado en España y su variación.
Analizando estos dos parámetros vemos que en 2019 el número de granjas permanecía estable respecto de los años anteriores (5.024 en 2012 frente a 4.989 en 2018, -0,7%) y la producción aumentaba (605 millones frente a 695 millones de pollos, +14,9%).
Sin embargo, los datos disponibles en 2025 denotan un cambio importante a la baja en cuanto al número de granjas (4.983 granjas en 2018 frente a 4.568 en abril de 2025, -8,4%) y un aumento sostenido en cuanto a la producción (695 millones frente a 771 millones de pollos en 2024, +10,9%).
En conjunto y desde 2012 el número de granjas ha disminuido en un 9,1% y la producción ha aumentado en un 27,4%, lo que influye notablemente en la estructuración del sector de la avicultura de carne.
Como causas de la disminución del número de granjas podemos barajar varias:
Cese de actividad,
Falta de recambio generacional,
Cambio en la especie avícola a criar (pavo),
Pérdida del REGA, Industrialización del entorno,
Migración a otras zonas con trabajos en horarios más normalizados...
En cuanto al aumento de la producción hay 2 causas que sobresalen:
Un aumento del consumo de carne de pollo pasando de 24,3 kilos/habitante/ año en 2012 hasta 30,1 en 2024 (similar en los 5 años anteriores), con previsión de mantenimiento en 30 kilos en 2025, +23,5%.
Un aumento de la población residente en España, debido a la inmigración, desde 46,8 millones en 2012 hasta 49,2 en abril de 2025, +5,1%.
Estos 2 hechos: disminución del número de granjas y aumento de la población residente, hacen que hoy día la búsqueda de granjas sea más complicada influyendo en el aumento del pago a granja por parte de las empresas integradoras (verticalización > 95%) y en el aumento de la productividad en granja.
La producción actual se sitúa en 168.780 pollos/año/granja (771 millones/4.568 granjas). Utilizando una ratio de 5,5 camadas/año da una camada media de 30.688 pollos en 2024, que comparado con los 25.268 del año 2018 nos da un aumento medio de +5.450 pollos/granja, el + 21,5%.
Por ello, tomamos como tamaño medio de la camada en 2025 los 30.700 pollos.
La razón de este aumento es doble:
Hay una disminución de las granjas antiguas, pequeñas y menos eficientes, usualmente de tamaño menor a 20.000 plazas.
Un aumento de granjas más modernas, grandes y productivas (anchura y densidad), y de tamaño mayor a 30.000 plazas.
Los últimos datos disponibles de tamaño de granjas en España se exponen en el cuadro siguiente:
Si aunamos los tamaños en 3 tramos, (< de 30.000, de 30.000 – 50.000 y > de 50.000) vemos que en el primer tramo se sitúan el 37,7 % de las granjas, en el segundo el 38,0 % y en el tercero se sitúan sólo el 24,3 % de las granjas.
Sin embargo, ese tercer tramo es responsable de la producción del 52,1% de los pollos enviados a las plantas de procesado, mientras que el 47,9 de la producción anual está cebado en el 75,7% restante de las granjas.
También Galimetría ha elaborado un cuadro al respecto y los datos publicados corroboran lo ya expuesto por el MAPA, ya que la mayoría de las granjas tienen un tamaño menor de 35.000 pollos (62,2%) y las mayores a esta cantidad solo representan el 38,1 %. Lo vemos en el siguiente cuadro:
Tabla 2. Galimetría 2024.
Por otro lado, nosotros buscamos una granja tipo sobre la que aplicar los parámetros productivos y estudiar los ingresos y gastos propios del cebo de los pollos de carne.
Sin embargo, no es posible encontrar una granja tipo sobre parámetros técnicos, productivos o constructivos. No sería válida una elección según antigüedad, tamaño, densidad aplicada, etc. Caracterización de las granjas por
Tabla 1. MAPA 2023.












Por su demostrada eficacia y seguridad, LIDERFEED es el ÚNICO GENUINO PROMOTOR DE CRECIMIENTO español aprobado por EFSA para la UE


Plaza García Lorca, 15 Bajos
Tfno: (+34) 977 552316
43006 Tarragona (Spain) email: lidervet@lidervet.com
(Register of Feed Additives pursuant to Regulation (EC) Nª 1831/2003 – Annex I.List of Additives https://ec.europa.eu/food/sites/food/files/safety/docs/ animal-feed_additives_eu-register_1831-03.pdf)


En el caso de elegir según el tipo de ventilación, tampoco se puede realizar. En el cuadro siguiente, vemos la disparidad de tipos de ventilación usados, siendo la más usual la ventilación transversal con refrigeración (44 %) que a su vez no representa a las granjas construidas más recientemente.
Tipo de Ventilación
Transversal ST (estándar) 14,6 Transversal AC (Refrigeración) 44,0
Túnel AC (Refrigeración) 16,7
Biclima AC (Refrigeración) 6,2
Tabla 3. Galimetría 2024.
Elegimos por tanto 4 naves tipo diferentes, como en estudios anteriores, que representen a los diferentes tipos de explotaciones existentes en España.
Utilizamos una combinación de antigüedad de la explotación, tipo de sistema de ventilación instalado, anchura y longitud de la nave, uso de 2 alturas o solo una, y tamaño de la nave.
El cuadro siguiente reúne estas características en cada tipo de nave.
Parámetros de la explotación
En cuanto al tipo de ventilación expuesto en el cuadro anterior hay que decir que:
Las naves tipo I disponen de ventilación natural o bien se ha adaptado a ventilación mixta por la instalación de ventiladores que no producen una entrada regulada de aire y que por otro lado no dispone de refrigeración como tal.
Las naves tipo II se han construido con un sistema de ventilación forzada que dispone de refrigeración evaporativa bien sea por humidificadores o por paneles evaporativos y que suele ser de tipo transversal.
Las naves tipo III y IV, con una construcción cercana en el tiempo, serían naves LTC, con control sobre temperatura y luz (son naves tipo llave en mano).
Antigüedad > 25 años 10-15 años < 10 años < 10 años Ventilación
Tabla 4. Elaboración propia 2025.
Otro dato que no ayuda a elegir una granja estándar es el tipo de crianza que se lleva a cabo, ya que, aunque este estudio no se realice sobre pollo campero, ecológico, de crecimiento lento, etc., sino sobre granjas donde se realiza el cebo de pollo de carne (broiler), lo cierto es que existen diferencias importantes en la crianza según sexaje o destino de los pollos, ya que se puede tratar de:
Pollo destinado exclusivamente para “pollo de asadero” o para “pollo tradicional” o “pollo estándar”.
Camada con la densidad ajustada o sin ajustar a despoblamiento parcial para asadero (20-50%).
Pollo sexado o sin sexar en sala de incubación (“pollo mixto”).
Entradas alternativas por sexo en granja o especialización en un sexo o crianza con sexos separados, en la misma nave o en naves diferentes dentro de la misma explotación.
Hay que comentar también que, como actualización de los parámetros productivos utilizados en el anterior estudio de 2019, consideramos que el PM (Peso Medio) del pollo de asadero es de 1,950 y que salen a este destino el 25% de los pollos. El peso medio del pollo tradicional es de 2,950 y salen el 75% restante de los pollos.
Con ello, el peso medio global aumenta hasta los 2,710 kilos.
Se produce también una mejora del Índice de Conversión (IC) y de la Ganancia Media Diaria (GMD). Se ajusta el porcentaje (%) de bajas y de lotes/año y se aumenta la retribución del avicultor como consecuencia de la escasez de granjas por ajuste de contratos y también aumenta por genética, ajuste de la densidad/m2 y de lotes/año.
Con todo ello, los parámetros técnicos en que basamos el presente estudio están reflejados en el cuadro siguiente:

Tabla 5. Elaboración propia 2025
Con los datos anteriores se producen las siguientes cantidades de animales, kilos y € que se reflejan en el cuadro siguiente de parámetros económicos:
Parámetros
Ingreso/pollo
Ingreso/m2/ año (€)
Este cuadro sirve de guía para realizar todas las operaciones matemáticas necesarias para asignar los céntimos de euro (ct€) de cada uno de los costes parciales, ya que a partir de este punto será prácticamente el único concepto manejado en este estudio.

Con los datos anteriores, tanto técnicos como económicos, elaboramos un cuadro que nos sirva de guía para asignar los gastos en cada tipo de granja. Se expresa a continuación:

El total de ingresos/pollo expresado en ct€ y que nos servirá para comparar con los gastos generados en la crianza y para determinar las pérdidas y ganancias de la actividad, es el siguiente:
Ingresos por actividad de cebo
8. Elaboración propia 2025



1 2 3 4 5
Una vez fijados los parámetros que determinan los ingresos de las granjas por el desempeño de la actividad de crianza y engorde de pollos para carne podemos analizar los diferentes apartados que determinan los costes de producción, que los vamos a segmentar en 5 bloques diferentes:
Las amortizaciones referidas a la inversión realizada en instalaciones, utillaje y todos los gastos accesorios derivados de la puesta en marcha de la actividad en la granja.
La mano de obra necesaria para desarrollar la actividad, tanto a través de terceros como de autoempleo, por lo que hablaremos de la UTH y su significado y del salario a percibir por el trabajador.
El consumo de la energía necesaria para efectuar una adecuada calefacción, ventilación, utilización de motores y para la iluminación.
Los gastos incluidos en la sanidad, como los medicamentos, acidificantes, limpieza, desinfección (DDD) y las analíticas realizadas.
Por último el bloque de otros gastos, como la cama o yacija, la carga de los pollos, el agua utilizada por la granja, los seguros contratados, los gastos generales de mantenimiento y el retorno del estiércol.
Desglosaremos a continuación cada uno de los bloques anteriores para continuar con un resumen en el que haremos una recopilación total de gastos y unas primeras conclusiones, pasando a categorizar los gastos por tipos de bloques y finalmente veremos algunas opciones de optimización. Comenzamos:
En el bloque destinado a inversiones y amortizaciones tenemos que distinguir las inversiones que se dedican a edificaciones e instalaciones (70% del total y amortización a 20 años) y a maquinaria y utillaje (30% del total y amortización en 10 años).
La amortización media sería de 17 años e incluye también los gastos accesorios realizados (licencias, permisos, estudios, proyectos, acometidas, obra civil, acondicionamiento, etc.).
Según el tipo de granja de que se trate la amortización pendiente sería:
Las naves tipo I están totalmente amortizadas,
Las naves tipo II están medio amortizadas (restan 8,5 años)
Las naves tipo III-IV están recién construidas (y queda la amortización total).
Hay que tener en cuenta además que el coste promedio de construcción y accesorios en las naves tipo II se sitúa en 150 €/m2 (menos automatizadas), siendo el de las naves tipo III-IV de 245 €/m2 (las naves tipo I tienen un coste inicial indeterminado y anticuado tanto por el material utilizado como por los conceptos y métodos usados para su construcción).



Por otro lado, los recursos utilizados para realizar esta inversión serían de origen bancario (70%) o extrabancario y propio (30%), y el interés aplicado del 3,25% anual.
Santander (Fija
10. Elaboración propia 2025
Aunque en este cuadro el interés aplicado es inferior al 3,25 % lo mantenemos a este nivel debido a que el interés mostrado sería el mínimo, que se incrementa según los riesgos, cantidad de hipoteca concedida, porcentaje sobre el total de la inversión y el número de años necesarios para realizar la amortización.
Con los datos anteriores elaboramos el siguiente cuadro donde mostramos un resumen del coste total de amortizaciones según el tipo de nave:
Se incluyen como inversión las comisiones cobradas y no se tienen en cuenta ni las posibles subvenciones ni los periodos de carencia obtenidos.
Mostramos a continuación un cuadro con las mejores ofertas de préstamos hipotecarios a interés fijo en el mes de mayo de 2025:
11. Elaboración propia 2025
Por último, hay que comentar que dentro del coste de amortizaciones se pueden medir distintas variaciones desde el estudio anterior del año 2019.
A este respecto el coste de construcción en 2019 se situaba en 160 €/m2 (coste medio entre todos los tipos de nave) frente a los 215 €/m2 en la actualidad, con un aumento de 55 €/m2 (+ 34,4 %).
También el interés bancario ha aumentado desde el 2,00 % en 2019 hasta el 3,25 % de media en 2025, lo que significa un aumento del 1,25 % (+ 62,5 %).
La necesidad de mano de obra en el sector agroganadero se expresa en UTH. El Real Decreto 1887/1991 sobre mejora de las estructuras agrarias lo indica en su artículo 2.12. “Unidad de trabajo/ hombre (UTH), la cantidad de trabajo que un trabajador activo agrícola desarrolla durante 1.920 horas al año”.
Con posterioridad el Convenio colectivo estatal para granjas regula una cantidad menor de horas.
Concretamente, el Convenio de 2021 y las tablas de 2024 regulan 1.780 horas al año.
Nosotros entendemos (al igual que otros autores) que 1 UTH en las granjas avícolas de pollos de carne (1 persona a salario completo) podría manejar adecuadamente 4.000 m2 y 60.000 pollos como mínimo, dependiendo del nivel de automatización de la explotación.
Por este motivo aplicamos:
Tipo I - II - III: ½ UHT en granjas
Tipo IV: 1 UHT en granjas
Nosotros utilizamos el Convenio colectivo para granjas avícolas (BOE 31/07/2024) y las tablas salariales provisionales de 2024.
De acuerdo con el hilo del artículo publicado en 2019 buscamos una persona muy cualificada sin estudios superiores, pero con algún certificado de capacitación para trabajar en granjas, y le aplicamos la máxima categoría (Técnico No Titulado).
Haciendo una definición más nítida tenemos a un varón de 46 años, casado y con 2 hijos (18 y 23 años), sin otro trabajo por cuenta ajena y cuya consorte no obtiene ingresos de más de 1.500 €/mes.
En muchos casos (la mayoría) el trabajador descrito será el mismo empresario emprendedor.
El desglose del salario a percibir por el trabajador lo extraemos de las tablas 2024, donde se especifica el salario bruto anual de 22.368,60 €, un plus de domingos y festivos de 709,20 € (50% de domingos + 14 festivos = 40 días x 17,73 €), lo que da un salario bruto total anual de 23.077,80 € (15 pagas de 1.538,52 €.
La aportación a la Seguridad Social sería de 124,62 € (x12) y el IRPF (7,10%) de 109,23 € (x15).
La percepción neta para el avicultor sería de 1.538,52 - 124,62 - 109,23 = 1.304,67 € (x12) y de pagas extraordinarias de 1.538,52 - 109,23 = 1.429,29 € (x3).
El coste para la empresa avícola sería el salario anual Total = 23.077,80 € más la aportación de la empresa a la Seguridad
Social = 34,07% del salario bruto anual = 7.862,61 €/año (655,22 €/mes x 12). Por tanto, el coste sería de 23.077,80 + 7.862,61 = 30.940,41 € (2.578,37 €/mes x 12).
Salario bruto total anual para el avicultor: 23.077,80 €
Percepción neta del avicultor: 1.304,67€ + pagas extraodinarias
Coste de la empresa salario anual: 30.940,41€
Ya tenemos definido el coste de 1 UTH: 30.940 €.
En caso de que el trabajador sea el mismo empresario y se trate por tanto de autoempleo la aportación que hace la empresa a la Seguridad Social de 655,22 €/mes es sustituida por el seguro de autónomos.
Este seguro, sin tener en cuenta tarifas planas o beneficios fiscales relacionados, tiene un coste de 295 €/mes en este tramo salarial.
Por tanto, hay un saldo favorable de (655 – 295) 360 €/mes, que se puede aplicar a realizar una mayor aportación a la Seguridad Social, contratar un plan de pensiones o inversiones, mejorar la cobertura sanitaria contratando un seguro privado o bien pagar la aportación de la empresa en caso de contratar a un tercero.
El cuadro resumen de la asignación de mano de obra (UTH) a los distintos tipos de naves sería:
Por último, dentro de este bloque, reseñar que el coste de mano de obra ha aumentado respecto al estudio anterior. En 2019 el coste de 1 UTH/año se situó en 24.507 €/año, frente a los 30.940 €/año de coste en 2025, con un incremento de 6.433 €/año (+ 26,3 %). Como causas de este aumento global se sitúan el Convenio colectivo (+ 20,8 %), el Plus de domingos y festivos (+ 3,8 %) y el aumento de cotizaciones a la Seguridad Social (+ 1,7 %).
El consumo de energía tiene 3 componentes diferentes:
Calefacción
Ventilación y motores
Iluminación
En cuanto al tipo de fuente de energía utilizada, la calefacción se efectúa normalmente con biomasa o combustibles fósiles y tanto la ventilación y los motores como la iluminación se realizan con electricidad.
La utilización de biomasa para calefacción se efectúa fundamentalmente con cáscara de almendra (también de albaricoque o melocotón) o con hueso de aceituna.
Ambas tienen un PCI (Poder Calorífico Inferior) de unas 4.300 kcal/kilo.
El precio en el último mes (mayo de 2025) oscilaba entre los 90 €/Tm de cáscara de almendra y los 120 €/Tm del hueso de aceituna.
El precio medio adoptado sería de 105 €/Tm de producto (10,5 ct€/kilo de biomasa).


Los combustibles fósiles utilizados con más frecuencia son el gasoil (tanto B agrícola o C calefacción, según disponibilidad y precio) con PCI de 10.200 Kcal/kilo y precio en el último mes (mayo de 2025) de 1.020 €/Tm (1,02 €/litro), y los GLP (Gases Licuados del Petróleo) en general y el propano en particular con PCI de 11.000 Kcal/kilo y precio de 1.350 €/Tm (1,35 €/litro).
En cuanto a la disponibilidad de la biomasa los datos son los siguientes:
La cosecha 2024-2025 de aceitunas en España se prevé que sea de 6.050.000 Tm, que con un rendimiento en hueso del 7,0 % da una cantidad de hueso de aceituna de 423.500 Tm.
La cosecha 2024-2025 de cáscara de almendra se prevé que sea de 375,000 Tm, que con un rendimiento en cáscara del 65% (rendimiento medio, oscilante según variedad) da una cantidad de cáscara de almendra de 243.750 Tm.
En cuanto a los factores que influyen en el coste de la calefacción son la localización de la granja, su climatología, época del año, tipo de combustible, así como su disponibilidad y precio, pero el factor con mayor influencia es el aislamiento de cada explotación.



:
A este respecto el IDAE (Instituto para la Diversificación y Ahorro Energético, dependiente del Ministerio de Industria) estima que una nave avícola bien aislada tiene un KG (Coeficiente de transmisión térmica global) de 0,45, mientras que una nave avícola mal aislada tiene un KG de 1,04 siendo la diferencia de 2,3 a 1.
Por este motivo, consideramos que sería muy conveniente realizar una auditoría en cada granja sobre el aislamiento existente (incluyendo un estudio termográfico pormenorizado) y las mejoras que se deben implementar en la explotación.
El coste de la calefacción lo realizamos en referencia a la biomasa, que es el combustible más usado. Ya dijimos que el precio medio es de 0,105 €/kilo (0,090 –0,120) y dándole un valor calórico = 1 para poder comparar con combustibles fósiles. El consumo según tipo de nave sería de 1,00 kilo/pollo en naves tipo I de 0,60 kilos/pollo en naves tipo II y 0,35 kilos/ pollo en naves tipo III y IV.
El coste se sitúa
Tipo I: 10,5 ct/pollo en naves
Tipo II: 3 en naves
Tipo III - IV: 3,4 ct$/pollo en naves
En cuanto al valor calórico que decidiría el cambio de combustible a utilizar usando los precios actuales indica que a día de hoy el propano o los GLP tienen un precio superior al de la biomasa en 5,4 veces y el gasoil de 4,1 veces.
Tabla 13. Elaboración propia 2025
La fuente energética usualmente utilizada es la electricidad. Por ello desglosamos el coste de esta fuente de energía con más detalle.
Utilizamos las tarifas de empresa, no las de consumidores particulares, siempre de baja tensión (<1 KV) bien sea monofásica (de menor consumo punta, 220 V de tensión normalizada y potencia contratada <15 KW) o trifásica (para un consumo punta más elevado, 400 V de tensión normalizada y potencia contratada >15 KW).

Utilizamos las tarifas ofertadas por Endesa para el mes de mayo de 2025. Concretamente la tarifa 2.0 TD (monofásica) a 0,157 €/kw y la tarifa 3.0TD (trifásica) a 0,133 €/kw. El precio medio utilizado es de 0,145 €/kw.
La contratación de potencia tiene un coste de 0,136 €/kw en monofásica y de 0,138 €/kw en trifásica. En el caso de la Nave Tipo I contrataríamos 5,5 kw/día con la tarifa 2.0 TD y con un coste de 22,75 €/mes. En las naves tipo II, III y IV contrataríamos 15,0 kw/ día (o más) con la tarifa 3.0 TD y con un coste de 63,17 €/mes. El precio utilizado sería de 0,139 €/kw (por si la contratación es mayor).
El consumo de electricidad para la Ventilación y motores sería de:
Tipo I: 0,00 kw/pollo salido en nave
Tipo II: 0,25 kw/pollo salido en nave
Tipo III - IV: 0,15 kw/pollo salido en naves.
El coste del consumo eléctrico en ventilación se sitúa en:
Tipo I: 0,5 ct€/pollo en naves
Tipo II: 4,2 ct€/pollo en naves
Tipo III: 2,5 ct€/pollo en naves
Tipo IV: 2,4 ct€/pollo en naves.
En la iluminación solo contemplamos la correspondiente al tipo LED, para la cual el consumo sería de 0,7 kw/pollo salido en naves tipo I-II y de 1,6 kw/pollo salido en naves tipo III-IV.
El precio utilizado de energía es igual al del anterior apartado, 0,145 €/kw. No se contempla nuevo coste de potencia.

Medidas estándar de10m. 12,5m. 14m.de ancho 10m 12,5m 14m
Ventilación y aislamiento excepcional Proyectos llave en mano
Las más de 550 naves de experiencia nos avalan

Cobertizos Ganaderos Cosma
almacenamiento, refugio, ganado, etc.


Polg. Ampliación Comarca I
Sin necesidad de proyecto
Calle M, nº6 - 31160 ORCOYEN (Navarra) Tel 948 317 477 Fax 948 318 078 cosma@cosma.es www.cosma.es







TÚ TIENES EL INSTINTO DE PROTEGER. NOSOTROS EL DE PROTEGER RÁPIDAMENTE.
Introducing Poulvac® Procerta™ HVT-IBD. La protección temprana lo es todo en la producción avícola, por ello Zoetis ha creado su novedosa vacuna vectorizada para que manejes el tiempo a tu favor. El resultado de nuestros últimos avances científicos es Poulvac® Procerta™ HVT-IBD, que protege de forma completa y rápida frente a virus virulentos, muy virulentos y variantes1-4 de la enfermedad de Gumboro. En

El consumo corresponde en naves tipo I-II al suplemento de luz hasta las 12,5 horas de fotoperiodo medio y en naves tipo III-IV al coste de iluminación total en todas las épocas del año.
Por tanto, el coste del consumo eléctrico en iluminación se sitúa en:
Tipo I - II: 0,1 ct€/pollo en naves
Tipo III - IV: 0,2 ct€/pollo en naves.
Vemos un resumen del coste energético en el cuadro siguiente según el tipo de nave de que se trate:
Se incluyen todo tipo de medicamentos y aditivos para agua exceptuando los acidificantes. Por tanto, abarcan:
Las vacunas (van a cargo exclusivo del integrador y con tendencia a ser administradas en la sala de incubación in ovo o al nacimiento)
Los antibióticos (con cargo compartido o exclusivo del integrador, con tendencia a la total desaparición de su uso),
El coste del consumo de medicamentos lo situamos en:
Tipo I: 0,8 ct€/pollo en naves
Tipo II: 0,5 ct€/pollo en naves
Tipo III-IV: 0,3 ct€/pollo en naves igual que en 2019.
Por último, hay que comentar que el coste energético ha variado desde el estudio anterior del año 2019 en la siguiente proporción:
La dosis utilizada es la misma (1 kilolitro/1.000 agua). El consumo de agua de bebida también es el mismo ( Naves Tipo I: 8,5 litros/pollo; Tipo 2: 7,9 litros/pollo; Tipo III: 7,4 litros/pollo; Tipo IV: 7,4 litros/pollo). Tabla 14. Elaboración propia 2025
Se tratan de forma independiente. Su uso puede variar desde unos pocos días, utilización de forma alterna o prácticamente durante toda la vida del pollo.
El precio aplicado es de 2,0 €/kilo/litro de producto (1,5 – 2,5).
En 2019 el precio usado fue de 1,50 €/kilo/litro.
El coste por consumo de acidificantes sería de:
Tipo I: 1,7 ct€/pollo en naves
Tipo II: 1,6 ct€/pollo en naves
Tipo III-IV: 1,5 ct€/pollo en naves.
Estos gastos de limpieza incluyen 2 cuestiones diferentes:
Cada camada se necesita el uso de un tractor, camión, equipo de alta presión y mano de obra propia (45 €/ hora: 350 m2, ratio de 130 €/1.000 m2).
Además, normalmente se necesita un Ayudante de limpieza (50 €/1.400 m2, ratio de 36 €/1.000 m2).
Cada año se necesita realizar una o varias limpiezas extra con detergente espumante por equipo externo especializado (lucha contra salmonella) que se realiza como mínimo de forma anual (700 €/ año/1.100 m2 -mínimo y proporcional para más m2-, ratio de 640 €/ año/1.000 m2).
El coste de este capítulo de limpieza sería de:
Tipo I: 3,0 ct€/pollo en naves
Tipo II: 2,2 ct€/pollo en naves
Tipo III-IV: 1,9 ct€/pollo en naves.
Siempre realizada por empresa externa, con emisión de Certificado de DDD, con protocolo de actuación consensuado con el responsable técnico de la integración.
Debe combinar la desinfección del interior de la nave, zona externa adjunta, silos, almacenes, etc. Y realizada con productos comerciales a alta y baja presión y mediante termonebulización.
Debe también incluir la comprobación de la eficacia de los controles de insectos y roedores y el mantenimiento de los portacebos instalados (que ya puede hacerse de forma remota).
El coste de la desinfección es de 270 €/1.100 m2, mínimo y proporcional para más m2
El coste de este capítulo de desinfección sería de:
Tipo I: 2,6 ct€/pollo en naves 2,0 ct€/pollo en naves 1,7 ct€/pollo en naves.

Se realizan obligatoriamente 3 tipos de
Autocontrol de Salmonella (calzas), 21 días antes de la salida. Dos autocontroles si hay despoblamiento parcial. Coste de
Control de Salmonella tras desinfección (paño humedecido). Coste de 36 €/camada.
Analítica de agua de bebida: Aconsejamos 2 analíticas del año. Coste de 14 €/camada (40 € x 2 analíticas / 5,7 camadas =

Los programas de rotación eficaces requieren coccidiostatos de confianza. Nuestras soluciones recién adquiridas:
(lasalocid, ionóforo divalente)
(ionóforo glicósido)
(robenidina, químico) (decoquinato, químico)
Te ofrecen la flexibilidad y la confianza necesarias para combatir la coccidiosis y optimizar el rendimiento de tu explotación.
¡Consúltanos para definir la mejor estrategia para tu granja!
Conozca más sobre nuestros productos






Los costes anteriores incluyen el material utilizado y el envío a laboratorio. Por otro lado, en determinadas OCAs pueden estimar como obligatoria la realización de una analítica de Legionella. El precio sería de 35 €/análisis (no se incluye en el coste).
El coste de este capítulo de las analíticas obligatorias sería de:
Tipo I: 1,1 ct€/pollo en naves
Tipo II: 0,5 ct€/pollo en naves
Tipo III-IV: 0,4 ct€/pollo en naves.
Como resumen de los gastos incluidos en el bloque de sanidad exponemos el siguiente cuadro:
Consumo de sanidad (ct€/ pollo)
Tabla 15. Elaboración propia 2025
Por último, en este apartado de sanidad, hay que comentar que el coste ha variado desde el estudio anterior del año 2019 de forma dispar y aumentando enormemente en el caso de que haya intervención de personas y empresas externas a la granja (Tractor + ayudante, limpieza anual y desinfección externa):
En su totalidad los gastos incluidos en el bloque de Sanidad han experimentado un aumento desde 6.624 €/año en 2019 hasta 12.682 €/año en 2025, por tanto, de 6.058 €/año más (+ 91,5%).
La cama es un insumo necesario en la crianza de los pollos y muy importante, ya que está en permanente contacto con ellos. Como materiales de cama usados se sitúan:
La cascarilla de arroz (con capacidad absorbente del 170%, se presenta en alpacas de 300 - 400 kilos),
El pellet de cama higienizado (con capacidad absorbente del 300%, se presenta a granel, a base de paja higienizada de cereales con absorbente)
La viruta de madera (con capacidad absorbente del 190%, se presenta a granel), el molido de madera (con capacidad absorbente del 100 - 160%, se presenta a granel)
La paja picada (con capacidad absorbente del 85%, se presenta en alpacas de 300 – 400 kilos)
Las zonas de producción de la cascarilla de arroz son en 2025: Cataluña (33%), Comunidad Valenciana (29%), Extremadura (27%) y situándose el 11% restante en otras CCAA.
Las zonas de producción de la paja de cereales son en 2025: Castilla y León (42%), Castilla la Mancha (18%), Andalucía (8%) y el 32% restante en otras CCAA.
La zona de producción del pellet de cama higienizado está situada en la zona centro peninsular.
Es importante saber cuáles son las zonas de producción porque el precio de los materiales de cama usados depende de los centros de distribución disponibles, de su distancia a la granja, de la cantidad de material de cama a enviar y de la presentación de la misma.
El coste en destino de material de cama sin prensar y a granel es de unos 130 €/Tm. Y el material de cama ya prensado y presentado en alpacas es de 150 – 180 €/Tm (incluido el pellet de paja o madera a granel). El precio medio que aplicamos de 150 €/Tm (15 ct€/kilo).
La cantidad usada de cama oscila entre 3,5 – 5,0 kilos/m2/camada (5,0 kilos en naves tipo I, 4,5 kilos en naves tipo II y 3,5 kilos en naves tipo III-IV.
El coste de este capítulo de cama o yacija sería de:
Tipo I: 7,9 ct€/pollo en naves
Tipo II: 5,5 ct€/pollo en naves Tipo III-IV: 3,7 ct€ en naves.
La carga de los pollos, como último acto de la crianza en sí de los pollos en la granja, suele ser realizada por un equipo externo de carga, que es también externo a la empresa integradora y que realiza esta labor con personal debidamente legalizado.
La logística de esta operación se centraliza en la empresa de carga, que la realiza atendiendo a las necesidades de la planta de procesado usual.
La forma de realizarla suele ser mediante carga manual en los cajones de jaulas de carga introducidos con torillo en el interior de la nave y transportados una vez estén llenos hasta el camión situado en la entrada del muelle de carga.
El número de cargadores debe ser tal que facilite la manipulación de los pollos, minimice la producción de canales de segunda derivados de la carga y no aumente los costes de movilidad de los cargadores.
El coste está compartido entre integrador e integrado, con diferentes porcentajes de participación dependiendo de la disponibilidad de estos equipos en la zona y de lo estipulado en el contrato de integración.
A estos efectos la empresa integradora pasa la factura de carga en la liquidación de la camada de pollos. El coste de este capítulo, y que se aplica al avicultor, siempre expresado en ct€/pollo salido oscila entre 3,5 – 4,0 ct€/pollo.
En este estudio utilizamos un coste de 3,5 ct€/pollo salido.
Una explotación de pollos de carne utiliza agua para 3 finalidades diferentes:
Como agua de bebida (fundamentalmente)
Para la limpieza de la explotación
Para la refrigeración evaporativa.
El consumo de agua de bebida es de 1,6 - 1,8 litros/kilo de pienso, dependiendo del tipo de nave (por variación del tipo de bebedero y del consumo de pienso).

Sería de 1,8 en naves tipo I; 1,7 en naves tipo II y 1,6 en naves tipo III-IV. El consumo por pollo sería de 8,5 litros/pollo salido en naves tipo I; 7,9 litros/pollo salido en naves tipo II y de 7,4 litros/pollo salido en naves tipo III-IV.
El consumo del agua para limpieza es de 0,5 - 2,0 litros/pollo salido. Y el consumo de agua para refrigeración es de 0,5 - 2,0 litros/pollo salido.
Como consecuencia de la diferente dificultad para realizar estas labores en los distintos tipos de nave, estipulamos el consumo conjunto de agua para limpieza y refrigeración en 1,4 litros/ pollo salido en naves tipo I; 2,1 litros/ pollo salido en naves tipo II y de 1,0 litros/pollo salido en naves tipo III-IV.
Por tanto, el consumo total de agua en granja (bebida, limpieza y refrigeración) sería de:
Tipo I: 9,9 litros/pollo salido en naves
Tipo II: 10,0 litros/pollo salido en naves
Tipo III-IV: 8,4 litros/pollo salido en naves.
También de cara al coste hay que tener en cuenta que la procedencia del agua puede ser de pozo, doméstica, industrial, pantano, etc., y que la legislación permite un máximo de 2 acometidas diferentes.
El coste del agua, basado en el precio del agua de red es dispar, y lo fijamos en 3,00 €/m3. El precio del saneamiento y del canon lo podemos estipular en 0,03 €/m3 de agua utilizada. El precio total aplicado al agua de red sería de 3,03 €/m3
Por todo ello el coste del consumo de agua en general en granja sería de:
Tipo I-II: 3,0 ct€/pollo en naves Tipo III-IV: 2,5 ct€ en naves.
Entre los seguros de explotación están los de carácter oficial ofrecidos por Agroseguro dentro del sistema español de seguros agrarios combinados. Están:
Seguro oficial Línea 406: con cobertura de Influenza aviar, Newcastle y Salmonella, y como adicional muerte por incendio y humo, inundación, viento huracanado, rayo, nieve, pedrisco, golpe de calor y pánico. El coste es de 0,25 €/m2.
Seguro oficial Línea 415: con cobertura de retirada y destrucción de los animales muertos en la granja. El coste de 0,88 €/m2 (0,65 €/m2 si el contenedor es frigorífico).
Por último, se debe contratar el Seguro de retirada de residuos de medicamentos (envases): consistente en un contrato de gestión integral de residuos peligrosos. El coste es de 300 €/año (Naves Tipo I-IIIII) y 350 €/año (Nave Tipo IV).
El coste de este capítulo de seguros sería de:
Tipo I: 4,5 ct€/pollo en naves
Tipo II: 3,2 ct€/pollo en naves
Tipo III: 2,5 ct€/pollo en naves
Tipo IV: 2,4 ct€ en naves.
MANTENIMIENTO DE INSTALACIONES
Esta pequeña partida está destinada a conservar las instalaciones y utillaje, tanto el mantenimiento de las instalaciones debido al uso, como a la reparación y restauración del material deteriorado.
Contemplamos, al igual que en el estudio de 2019, la cantidad de 1,5 ct€/pollo salido en cualquier tipo de nave.
El estiércol, que se define como la mezcla de la cama original con agua más heces más plumas y que ha fermentado durante la crianza de los pollos, se utiliza en labores de fertilización agrícola y en consecuencia se valoriza, pudiendo tener 3 destinos diferentes:
Venta directa a un destinatario final o a través de un tenedor intermediario. Mediante autoconsumo cuando se utiliza en los terrenos del propio avicultor.
Mediante trueque cuando el avicultor lo cambia por cama nueva (pagando un suplemento de unos 225 €/1.000 m2).
Nosotros desestimamos el trueque, ya hemos puesto precio a la compra de cama, y utilizamos un precio medio del retorno de 380 €/1.000 m2/camada.
El retorno económico en este capítulo de retirada del estiércol sería de:
Tipo I: 4,0 ct€/pollo en naves
Tipo II: 3,1 ct€/pollo en naves
Tipo III-IV: 2,6 ct€/pollo en naves.
A continuación, exponemos un resumen del coste de este bloque de otros gastos desglosado en cada uno de los capítulos:
Consumo de otros (ct€/pollo) N. Tipo I N. Tipo II N. Tipo III N. Tipo IV
Cama o yacija
Carga de los pollos 3,5 3,5
Suministro de agua
de explotación
Mantenimiento de instalaciones 1,5 1,5
Retorno del estiércol
Tabla 16. Elaboración propia 2025
Por último, en este apartado de otros gastos, analizar que el coste ha variado desde el estudio anterior del año 2019 de forma dispar en cada capítulo:
Cama o yacija Carga de los pollos Suministro de agua Seguros de explotación Mantenimiento de instalaciones Retorno por valorización del estiércol
El resumen de los costes de granja resumido por bloques es el siguiente:
Y el resultado económico de la actividad de crianza y engorde de pollos de carne en granja sería el siguiente:
Y el resultado económico de la actividad de crianza y engorde de pollos de carne en granja sería el siguiente:
Resumen económico (ct€/pollo)
Ante estos resultados y como primera conclusión podemos afirmar que la actividad de crianza y engorde en las naves Tipo I-II NO es rentable.
Las naves tipo III y IV mantienen una rentabilidad de entre el 6 y el 7% (3,3 y 3,6 ct€/pollo) y que depende de los resultados técnicos y de los cambios contractuales que realice la empresa integradora según la situación del mercado. Por ello es aconsejable que en estas granjas se realice de forma previa una imputación correcta de las amortizaciones y salarios y se mantenga de forma permanente una optimización adecuada de los costes de todos los insumos que participen en el coste de explotación. Coste por bloques (ct€/pollo)
Tabla 18. Elaboración propia 2025
Las naves tipo I necesitan una profunda renovación y optimización o deberán más pronto que tarde afrontar el cese de la actividad.
Las naves tipo II necesitan realizar una optimización de costes en cada uno de los bloques anteriores, además de revisar exhaustivamente la eficiencia energética e hidrológica, todo ello para poder asumir una sostenibilidad integral de la explotación.
Por otro lado, los costes de la granja agrupados en estos 5 bloques pueden también categorizarse como costes fijos y variable, siendo los fijos independientes de la realización o no de la actividad de crianza y engorde en sí, y los variables los que se producen cuando se realiza la actividad de cebo.
Como costes fijos podemos clasificar las amortizaciones o arrendamiento de la explotación y la mano de obra (en el caso usual de ser autoempleo). Y como costes variables tenemos los insumos agrupados en los bloques de energía, sanidad y otros gastos.
Coste fijo/ variable (ct€/pollo)
Podemos comprobar también que los costes fijos son porcentualmente menos importantes (40% frente a 60%) en las granjas I-II y más importantes (56% frente a 44%) en las granjas tipo III-IV, que son más modernas y eficientes.
fijo/ variable (%)
En cuanto a la optimización a realizar según esta categorización en costes fijos y variables, podríamos incidir en los siguientes puntos:
Disponer de parte del capital a invertir.
Acceder a préstamos sostenibles (Tipo Fijo inferior al 3% de interés y con periodos de carencia).
Aplicar amortizaciones fiscalmente legales independientemente de la amortización del préstamo obtenido.
Suscribir todos los beneficios fiscales disponibles: subvenciones, bonificaciones de intereses, periodos de carencia, incentivos fiscales para la modernización agraria, etc.
Aplicar economía de escalas.
Optimización de la imputación de mano de obra (UTH).
En caso de autoempleo optimizar el dimensionamiento de la granja.
Periodificar los gastos imputables.
Revisión del aislamiento térmico de la granja. Esta acción sería para realizar de forma URGENTE.
Eliminación de puentes térmicos
Sustitución de ventanas por trampillas de aire.
Uso de recuperadores de calor.
Instalación de tetinas.
Cambio a iluminación LED.
Optimización de la densidad: sin menoscabar el bienestar animal y sin empeorar la calidad de las canales.
En general revisar posible optimización de cada uno de los puntos tratados en este estudio.
Actualización de costes en granjas de pollos DESCÁRGALO EN PDF
A continuación, presentamos la tabla resumen de todos los bloques y capítulos de coste, así como los ingresos obtenidos como retribución de la empresa integradora y el resultado conseguido, todo ello expresado en céntimos de euro por pollo salido (ct€/pollo salido).

En la mayoría de los casos, cuando no se logra la producción acumulada de pollitos deseada, la persistencia de la producción de huevos y la fertilidad deficientes son los principales impulsores.
El control de los siguientes puntos clave de gestión debe formar parte de una rutina de gestión diaria.
ETAPA DE RECRÍA
ENTORNO: temperatura, iluminación y ventilación
SINCRONIZACIÓN SEXUAL, PORCENTAJE DE MACHOS Y PLUMAJE DE LAS AVES
CONTROL DEL PESO
CORPORAL Y DEL HUEVO
CONDICIONES DE LA NAVE DE PRODUCCIÓN
La recría constituye la base del rendimiento final del lote, sin una gestión detallada de todos los aspectos durante la recría y en particular la uniformidad, el rendimiento futuro de la producción de huevos puede verse comprometido.
Un lote con problemas durante la recría es impredecible, con una disminución más rápida de la persistencia después del pico y, por lo tanto, una menor producción de huevos para incubar y de pollitos en comparación con un lote bien recriado.
Un lote en recría debe de contemplar:
Perfil de crecimiento que siga de cerca los estándares de peso corporal durante toda la recría y que alcance el peso corporal objetivo para hembras y machos sobre las 20 semanas.
Un fleshing y una buena conformación corporal adecuados para la edad.
Buena uniformidad de hembras y machos durante toda la recría, con un coeficiente de variación (CV%) de <8% o una uniformidad >79% al final de la recría.

La relación entre la temperatura efectiva (la temperatura que percibe el ave) y su efecto en el rendimiento de las aves suele pasarse por alto.
Muchas veces se alimentan a las aves con la misma cantidad de alimento para su edad durante todo el año, independientemente de la temperatura efectiva que experimentan.
Durante los meses más fríos, puede ser necesario aumentar la asignación de alimento o mantenerla en un nivel más alto y más estático a medida que la producción avanza durante el período más frío.
Los ajustes en el contenido de lisina digestible proporcionales a un aumento de energía son cruciales para mantener los volúmenes de alimento más altos y superar las bajas temperaturas sin que se produzca un aumento excesivo de peso corporal.
Durante los meses más cálidos, las aves pueden reducir la ingesta de alimento en respuesta al clima cálido. El suministro de agua fría puede ser útil.
Reformule la dieta para equilibrar la ingesta de alimento de modo que la ingesta de nutrientes satisfaga los requisitos de las aves.
Se deben considerar parámetros como la producción de huevos, el peso del huevo, la masa del huevo, el peso corporal y la cobertura de plumas antes de realizar cualquier cambio en consumo de pienso.

Tanto los machos como las hembras son fotorrefractarios, eso quiere decir que son incapaces de responder positivamente al estímulo lumínico largo o mayor de 11 horas.
Para que las aves puedan responder al estímulo lumínico y comenzar la producción, primero deben salir del estado de fotorrefractariedad.
Para lograrlo, es necesario exponerlas a un fotoperíodo corto, de 8 horas de luz diaria, durante al menos 18 semanas.
Se recomienda proporcionar una duración del día de 13 a 14 horas de luz en producción.
Proporcionar más de 14 horas de luz generalmente conduce a que el lote muestre una persistencia menor debido a la aparición avanzada de la fotorrefractoriedad adulta y la producción disminuye más rápidamente.
Ensayos de campo han demostrado una mejora en la producción de huevos al agregar 2 horas de luz después de las 50 semanas, lo que puede tener el efecto de una estimulación tardía de la luz en lotes con ambiente controlado donde el fotoperiodo no excede las 14 horas.

Es esencial resaltar la importancia de la ventilación y su vínculo con la persistencia de la producción. La ventilación debe ajustarse en función del plumaje, las condiciones ambientales y del comportamiento de los animales.
Una ventilación incorrecta puede:
Aumentar la cantidad de huevos en el suelo
Provocar secreción ocular
Reducir la producción de huevos, la viabilidad diaria y la fertilidad.
Cuando no hay sincronización sexual o
Si se observa una respuesta positiva en la producción total de huevos después de proporcionar las 2 horas adicionales de luz, un pequeño aumento temporal de la alimentación puede respaldar aún más la respuesta.

El comportamiento de apareamiento normal se ve afectado cuando una hembra no tiene la protección de una capa de plumas, ésta se vuelve menos receptiva y por lo tanto, se observa una reducción de la fertilidad a medida que el lote envejece.

Es importante asegurarse de que los machos y las hembras estén sincronizados en cuanto a la madurez sexual antes de aparearse.
Si la nave tiene corrales separados para los machos y existe variación en la madurez sexual dentro de la población de machos, los machos más maduros deben mezclarse primero con las hembras.
Esto garantiza que los machos más pequeños y menos maduros sexualmente tengan tiempo para desarrollarse y madurar antes de aparearse con las hembras.
Edad
Días Semanas
Número de machos de buena calidad por cada 100 hembras
154-168 22-24 9,50-10,00
168-2140 24-30 8,50-9,50
210-245 30-35 8,00-8,50
245-280 35-40 7,50-8,00
280-350 -40-50 7,00-7,50
350-Descartes 50-Descartes 6,50-7,00



Las tasas de apareamiento iniciales (22-35 semanas) suelen ser más altas que las recomendadas debido a la creencia incorrecta de que esto mejora los nacimientos.
Porcentajes de machos elevados conducen a un apareamiento excesivo, daño en las plumas, hembras no receptivas y una menor persistencia de la fertilidad después del pico.
Es importante verificar la fertilidad real para poder determinar la causa.

El peso corporal, la persistencia y los niveles de alimento deben gestionarse cuantitativamente.
Reducir el alimento de forma demasiado agresiva o sin permitir o compensar el sobrepeso de un lote puede provocar una disminución en la persistencia de la producción, alterando el equilibrio de la ganancia de peso corporal.
Aumentar el alimento demasiado rápido para que un lote vuelva al objetivo cuando tiene bajo peso generalmente empuja a las aves hacia el sobrepeso y reduce la producción de huevos.
Junto con el peso, controlar el peso del huevo diariamente permite trazar tendencias en comparación con el estándar para que las cantidades de alimento se puedan ajustar adecuadamente.
Una desviación en la tendencia creciente del peso del huevo se observa a menudo antes de una reducción en la producción de huevos y puede ser el primer indicio de un problema potencial.
El peso del huevo debe registrarse diariamente a partir del 10 % de producción diaria por gallina.
Al realizar cualquier ajuste en el nivel de alimento, es esencial considerar el impacto que esto tiene en la ingesta total de nutrientes en lugar de solo los gramos de alimento por ave por día.
Todos los huevos que no eclosionan (pequeños, con doble yema, agrietados y anormales, etc.) deben retirarse antes del pesaje.
Se debe de seguir unas pautas generales de reducción del pienso después del pico de puesta en función del peso corporal, peso del huevo, tiempo de consumo del alimento, condición corporal y producción:
Lotes con rendimientos por encima de los objetivos pueden estar recibiendo un suministro insuficiente de nutrientes, el peso corporal y el peso de los huevos podrían empezar a desacelerar


Las reducciones excesivas de alimento después del pico de puesta pueden tener un efecto negativo sobre la producción.

En estos casos las reducciones del alimento deben ser menores y más graduales; la cantidad máxima de alimento podría tener que mantenerse por más tiempo, el inicio de la reducción del alimento podría tener que retrasarse.
En Lotes con rendimientos por debajo del objetivo la reducción del alimento puede ser mayor.
Las cantidades en exceso de alimento causan sobrepeso, persistencia deficiente y mayor peso de los huevos.
La reducción global de alimento en estos lotes será mayor si se compara con lotes de mayor rendimiento.
Puesta ave/presente Peso del huevo (g) P/Hembra
Figura 3. Gráfico donde se ilustra un lote con un rendimiento por debajo del objetivo de producción semanal. Las líneas punteadas indican que ocurriría con el rendimiento si no se realizaran ajustes apropiados a las reducciones de alimento
175(25)
Objetivo del peso corporal
Objetivo de peso huevo
Objetivo de % de producción semanal gallinas 189(27) 203(29) 217(31) 231(33) 245(35) 259(37) 273(39) 287(41) 301(43) 315(45) 320(47) 343(49) 357(51) 371(53) 385(55) 399(57) 413(59) 427(61) 441(63)
Peso corporal real Peso real del huevo % real de producción semanal gallinas
Figura 2. Gráfico donde se ilustran los efectos de distribuir alimento insuficiente a una parvada con un rendimiento por encima del objetivo de producción semanal de las gallinas. Las líneas punteadas indican qué ocurriría con el rendimiento si no se realizaran ajustes apropiados a las reducciones del alimento.
Peso del huevo (g) PV Hembra PESO DEL HUEVO
Figura 4. Ejemplo de un lote con un rendimiento por encima del objetivo semanal donde el peso de los huevos y el peso corporal se está alejando del objetivo esperado de una manera constante y continua durante al menos 4 días.


El control de la temperatura ambiental, la iluminación, la ventilación, la condición corporal, los perfiles de peso corporal y de los huevos, las condiciones de alojamiento y los desafíos externos son esenciales para responder de manera eficiente y eficaz al rendimiento del lote.
Peso del huevo (g) PV Hembra
Figura 5. Ejemplo de un lote con un rendimiento por debajo del objetivo semanal donde el aumento del peso diario de los huevos y el peso corporal se vuelve continua y constantemente mayor que lo esperado durante al menos 4 días.
Las condiciones de las naves deben supervisarse periódicamente y se deben realizar ajustes cuando sea posible:
CONDICIONES DE LA NAVE
Densidad de la población
Gestión alimentación, comederos
Gestión de los bebederos
Calidad de la cama
El ajuste correcto de los niveles de alimentación, porcentaje adecuado de machos y la minimización de los desafíos dentro del lote permiten mejorar y mantener la persistencia posterior al pico de puesta en la producción de huevos y en la fertilidad.
Manejo para lograr una persistencia óptima después del pico de puesta DESCÁRGALO EN PDF
RECOMENDACIÓN
» Nivel recomendado (3,5-5-5 aves/m 2 )
» Espacio disponible para comederos, bebederos y nidales.
» Espacio de alimentación recomendado para las hembras:
» 15 cm/ave - pista - 10 cm/ave - plato
» Distancia mínima de 100 cm entre las líneas de comederos.
» Distribución del pienso sin encender las luces.
» Altura correcta del comedero
» Mantener el espacio de bebida recomendado: 6-10 aves/tetina
» Mejorar la disponibilidad y calidad del agua
» Ajustar a la altura correcta del bebedero
» Ventilación adecuada y correcta para mantener la cama seca
Se dice que la primera impresión es fundamental y, en nuestra industria, esto está relacionado con la calidad del pollito a la llegada de la granja.
Teniendo esto en cuenta, es muy importante contar con los procedimientos y herramientas que nos ayuden a evaluar la calidad de los pollitos en la planta de incubación, pero también al llegar a la granja y así poder hacer las correcciones para mejorarla.


En la planta de incubación es fundamental comprender si las condiciones de incubación fueron óptimas y, cuando sea necesario, hacer las correcciones para mejorar y asegurar que se envíe la mejor calidad a los clientes.

Por otro lado, durante el alojamiento, es importante no solo evaluar si la incubación fue buena, sino también verificar si las condiciones de almacenamiento y transporte fueron óptimas y, además, asegurarnos de que estamos recibiendo la mejor calidad.
administradores de criaderos y granjas para evaluar la calidad de los pollitos. Este documento organiza los factores en tres categorías: preincubación, incubación y post incubación.



Factores de preincubación que impactan en la calidad de los pollitos:
Nutrición de las reproductoras.
Estado de salud de las reproductoras.
Calidad de los huevos para incubar.
Almacenamiento de huevos y transporte a la incubadora.
Factores de incubación que impactan en la calidad de los pollitos:

Ambiente de incubación (temperatura, oxígeno, CO 2, ventilación, etc.).
Temperatura de la cáscara del huevo.
Transferencia.
Ventana de eclosión.
Sacarlos a tiempo.
Factores post incubación que impactan en la calidad de los pollitos:
Condiciones post nacimiento en incubadora (temperatura, humedad, ventilación y luz).
Condiciones de transporte (temperatura, ventilación y humedad).
Condiciones de crianza durante los primeros cuatro días después del alojamiento.
En esta primera parte, desglosaremos los factores de pre-incubación que impactan en la calidad de los pollitos

Como puede imaginar, la calidad de los pollitos comienza en la granja de reproductoras y finaliza unos días después del alojamiento. En este documento técnico revisaremos los factores más importantes que impactan en la calidad y cómo pueden evaluarlo los responsables de la incubadora en el momento del nacimiento y los granjeros en el momento del alojamiento.
La calidad del lote de reproductores determina la calidad del huevo incubable
Por ejemplo, un mal manejo de la alimentación que afecta el rendimiento y la calidad de la cáscara del huevo.
A medida que el lote envejece, la calidad de la cáscara del huevo disminuye. Mientras que las gallinas menores de 30 semanas de edad podrían producir pollitos más inmaduros que requieren las mejores condiciones de crianza (desarrollo del sistema termorregulador) y las gallinas mayores de 67 semanas producen huevos de peor calidad (calidad de cáscara y calidad interna).

Cualquier enfermedad que afecte la calidad de la cáscara del huevo y/o la calidad interna (bronquitis infecciosa) y la calidad y viabilidad del pollito (Salmonella spp, Escherichia coli, Mycoplasma, virus de la anemia del pollo, encefalomielitis aviar, etc.).

Es fundamental seguir los niveles recomendados de vitaminas y minerales de la guía de manejo porque no seguirlos podría dañar la calidad y fertilidad de los pollitos y/o la incubabilidad. Siempre revisa la etiqueta de la premezcla de vitaminas/minerales.
Esto es aún más crítico en condiciones de clima cálido y/o en situaciones de caída en el consumo de alimento.
Un agua subóptima podría llevar enfermedades, toxinas o altos niveles de minerales. Es sumamente importante verificar la calidad microbiológica del agua y una desinfección constante para prevenir bacterias o virus.
PESO DE LOS HUEVOS: Incubar huevos de al menos 50 g y de lotes de al menos 22 semanas de edad. Lo óptimo es incubar lotes de huevos con un peso promedio de 58 a 61 g (comience con 50 a 52 g) con buena uniformidad (>90%). Esto contribuye a tener una buena incubabilidad, ventana de nacimiento y calidad de los pollitos.
FORMA DEL HUEVO: Dependiendo de la anomalía es el grado de impacto en la incubabilidad (ver Tabla 1).
Incubar únicamente huevos con forma normal.

Anomalía % Incubabilidad
Normal 74
Puntiagudo 65
Redondo 63
Pequeño 62
Con gránulos 19 Arrugado 13
Tabla 1. Características de los huevos y el impacto en la incubabilidad. Adaptado de Banday y Bakat, 2014 3 6 4 5
DEL HUEVO: Una buena cáscara proporciona protección, una fuente óptima de Ca y homeostasis para un buen desarrollo embrionario. La edad, la nutrición, la estación y el manejo del lote influyen en la calidad de la cáscara del huevo.

Los huevos con peor calidad de cáscara son más susceptibles a la contaminación bacteriana afectando la calidad del pollito (ver Gráfico 1).
específica
Gráfico 1. Porcentaje de huevos de diferentes calidades de cáscara que contienen Salmonella viable 24 horas después del desafío por Salmonella spp. Cuanto mayor sea la calidad específica, mejor será la calidad de la cáscara del huevo. Adaptado de Sauter y Petersen, 1974
HUEVOS LIMPIOS: Utilice únicamente huevos limpios. Nunca utilice huevos del suelo.
Para prevenir huevos en el suelo y mejorar la utilización del nido, es fundamental lograr un buen entrenamiento en la crianza.

Las enfermedades, nutrición, calidad del agua, manejo, limpieza del nido (y de las cintas de huevos) y las características del equipo juegan un papel importante en tener huevos limpios.
Al incubar huevos sucios existe el riesgo de que nazcan pollitos que pueden tener una alta mortalidad debido a enfermedades bacterianas (ver Gráfico 2 y Tabla 2).
Tabla 2. Efecto de la limpieza de los nidos sobre el recuento de bacterias y la mortalidad acumulada en la segunda semana. Adaptado de Mauldin, 2008 (engormix.com).
Mortalidad acumulada en 2ª semana
limpio Ligeramente sucio
Gráfico 2. Impacto del grado de limpieza del nido en la mortalidad acumulada a la segunda semana. Adaptado de Mauldin, 2008 (engormix.com).
ALMACENAMIENTO DE HUEVOS:
Cuanto más tiempo se almacene, peor será la calidad del pollito. La investigación realizada por Tona (2003) demostró que cuanto mayor es el tiempo de almacenamiento de los huevos para incubar, peor es la calidad de los pollitos (ver Gráfico 3).
Además, el aumento de peso corporal 7 días después del alojamiento es menor en los pollitos nacidos de huevos almacenados durante un período prolongado (> 14 días).
3 días 18 días
Pollitos con puntuación del 100% Días de almacenamiento
Gráfico 3. Efecto de los días de almacenamiento sobre la calidad del pollito. Adaptado de Tona et al., 2003.

Se puede utilizar un período corto de incubación durante el almacenamiento de huevos (SPIDES) para mitigar el impacto del almacenamiento prolongado.

Temperatura de la sala de almacenamiento y de la cáscara del huevo
Temperatura fuera de la sala de almacenamiento
TRANSPORTE DE HUEVOS
PARA INCUBAR
Transportar los huevos para incubar en camión limpio y desinfectado. Exclusivo para el transporte de huevos para incubar.
La temperatura debe ser de 18 a 22°C y la humedad relativa (HR) del 40 al 60%.
Se debe evitar a toda costa la condensación en la cáscara del huevo porque la humedad en la cáscara del huevo perjudica el mecanismo natural de defensa del huevo contra los microorganismos y proporciona condiciones óptimas para la multiplicación de los estos.
Tabla 3. Predicción de si se producirá condensación si no se toman medidas adicionales. Adaptado de Gerd de Lange, 2011 (poultrysite.com). Para un rango más amplio de temperaturas y humedades, utilice un gráfico psicométrico.
La Tabla 3 se puede utilizar para predecir condensación cuando no se tomen medidas adicionales. desinfección constante para prevenir bacterias o virus.
Factores que afectan a la calidad del pollito: Parte I DESCÁRGALO EN PDF
Conmemoramos 80 años de excelencia en genética avícola, impulsando la productividad y calidad en la producción de huevos.
Agradecemos la confianza de nuestros clientes y aliados a lo largo de este camino.
Atte. Equipo H&N International



Bernardo. G. Aliseda y Ovometría estadística Madrid, España

Normalmente, a la hora de tomar una decisión de compra, nos apoyamos en toda la información que tenemos acerca del producto y en la comparativa con productos sustitutivos.
Esta información puede venir del vendedor, de la literatura, experiencias, etcétera.

Aquí viene el origen de este artículo: ¿cuántas veces, a la hora de escoger una gallina para un lote nuevo, te has hecho una tabla con los índices productivos de varias estirpes y los has comparado?

Gastar mucho tiempo en comparar datos productivos de las distintas estirpes es un ejercicio complicado y, a veces, puede ocupar largas horas.

Sin ir más lejos, para escribir el artículo, os confieso que he sudado la gota gorda.
Debido básicamente a que no es fácil encontrar los datos en internet: guías que no completan todo el ciclo, otras que sólo están disponibles para jaula pero no para alternativo, rangos amplísimos para un dato, tener que abrir más de 10 pestañas casi idénticas para encontrar la información que se necesita... Incluso datos distintos dependiendo si se escoge el folleto completo o su versión resumida.
Esto complica muchísimo hacer una buena comparación y al final se entiende que nos acabemos fiando del técnico de genética y del boca a boca antes de gastar tiempo en buscarlo por nosotros mismos.
Los objetivos de rendimiento de las casas de genética nunca se deben tomar como un dogma de fe, sino como un valor de referencia.
Cada lote debe valorarse dependiendo de la época del año, recría, alimentación, alojamiento… y, como sabe el lector, decenas de variables que hacen que los índices se acerquen más o menos a los objetivos que marca la casa de genética.
La meta del artículo no es dar el nombre de la estirpe que más dinero haga ganar. Es simplemente dar una herramienta más para escoger ese animal, proporcionar una guía práctica y estructurada para comparar indicadores clave y tomar decisiones informadas.
En este artículo, de dos partes, contrastaremos en la primera mitad las 4 estirpes Semipesadas o Rubias más usadas en el mercado español.
En el siguiente número de la revista, haremos lo propio con las 3 estirpes más usadas de gallinas Blancas o Ligeras.
Además, añadiremos como broche unas pinceladas de nutrición con costes, en un apartado conjunto.

Antes de explicar cómo se ha hecho la comparativa de las características de cada gallina, y para entender bien el mundo de las estirpes, hablaremos al inicio de cada una de las partes del artículo acerca de dos de los gigantes de la genética mundial: EW y Hendrix.
El grupo EW es un conglomerado empresarial fundado en 1928, perteneciente a la familia Wesjohann, y que comenzó produciendo ovoproductos.
En 1987 adquirieron las compañías Lohmann, Hy-Line y H&N. Dos décadas después se introdujeron en el mercado de la avicultura de carne comprando Aviagen (líneas de pollo y pavo) y, en 2018, Hubbard.
Sin olvidar que otro gigante de la genética de puesta, Novogen, entró en el grupo a principios de la presente década.
Actualmente, EW está formado por más de 20 empresas dedicadas a la nutrición animal, acuicultura, genética, agricultura, productos veterinarios y un largo etcétera.
Lo más importante, y siendo cautos, se puede decir que al menos el 70% de la genética avícola que se usa en el mundo, tanto de carne como de puesta, procede de EW.
Era importante mencionarlo y conocer la presencia de EW en el mundo.
Le llega el turno a Hendrix Genetics.
Esta empresa, con origen en el año 1923 y que pertenece (50-50) a un grupo inversor americano y a dos fundadores de Países Bajos, cuenta en su catálogo de gallinas con las famosas estirpes ISA, Bovans, Dekalb, Hisex, Babcock y Shaver.
Además, tiene otras especies como pavo (Hybrid), pollo (Sasso), salmón, truchas, gambas y cerdo (Hypor).

Automatiza la recogida y empacado de huevos
Las empacadoras Prinzen combinan un manejo cuidadoso con la velocidad, haciendo que la recogida de huevos sea rápida y sencilla. Las distintas configuraciones se adaptan a cualquier sala de recogida de huevos y ofrecen una visión general óptima de todo el proceso de empacado.
Nuestras empacadoras tienen distintas capacidades:
Prinzen 50............................... 18.000 huevos/hora
Prinzen 70............................... 25.200 huevos/hora
Prinzen 100............................ 36.000 huevos/hora
Speedpack 110..................... 40.000 huevos/hora
Speedpack 220..................... 80.000 huevos/hora

¿Conoces las automatizaciones de Prinzen? Contacta con nosotros
Empacadoras, pesadoras y clasificadoras, marcadoras de huevos, apiladores, paletizadores, cargadores de bandejas, y mucho más.


Agustin Martin Ramos
Area Sales Manager
698 437 354
agustin.martin@vencomatic.es
Vencomatic Ibérica S.L. 977 331 908 info@vencomatic.es C/ Pintor Fuster, 21 43205 REUS (Tarragona)

Nosotros hemos decidido no elegir.
PONTIPLUS se ha creado para responder a las problemáticas de los huevos y de las gallinas.
Aumento de la tasa de puesta
Mayores ganancias técnico-económicas
Mejora de la calidad de la cáscara



Volviendo a la comparación entre gallinas, y empezando con las Semipesadas, una cuestión importante, es escoger las estirpes, alojamiento y sobre todo los datos a comparar.
1º Estirpes de gallinas escogidas:
Lohmann Brown-Classic, ISA Brown, Hy-Line Brown, H&N Brown Nick.
Se han escogido estos animales gracias a los datos aportados por el equipo de Ovometría S.L, ya que son las 4 estirpes más usadas en España.
Si bien es cierto que dentro de la genética de Lohmann, se ha estado usando más la Brown Extra, pero por cambio de tendencia en el tamaño del huevo en España y debido a su menor uso en Europa, nos centraremos en la Brown Classic ya que es más la línea del futuro, que la Brown Extra.
2ºAlojamientoocódigodeproducción:
Las tablas que se han comparado son de producción “alternativa” o código 2. La producción en convencional (código 3) para el huevo marrón, cada vez es menor, aunque aún queden muchos lotes en jaula, desde luego, no es el futuro.
3º Datos por comparar:
Huevos por ave alojada, % de puesta…
Las casas de genética muestran en su catálogo datos en diferentes semanas de producción, pero si no profundizas más en ellos, se complica la comparación debido a la diferencia entre edades y a la variabilidad del dato.
Es difícil elegir los valores más importantes. Escojamos el valor que escojamos, habrá quien le ponga pegas.
Por ejemplo, el peso de huevo, alguien nos dirá que con luz y pienso se puede modificar, pero hay que escoger valores para el artículo.
Por eso profundizaremos en huevos por ave alojada acumulado, % de puesta, peso huevo por ave alojada acumulado, masa de huevo acumulada y se mostraran valores de pico de producción y persistencia.
Quizás sean los índices técnicos más importantes para la producción y los ajustaremos para que se comparen en edad, si fuese necesario.

Aclaraciones por gallinas:
Los valores de la Lohmann Brown-Classic en alojamiento alternativo solamente llegan hasta las 90 semanas en las guías oficiales.
Por lo tanto, para completar las tablas de comparación, se ha hecho una estimación del valor a 100 semanas de edad para las 4 tablas siguientes.
Los valores de las Hy-Line se dan en rangos.
Por ejemplo, para huevos ave-día a 100 semanas, el valor es de 461,2 - 481,8 huevos.

Este rango es de más de 20 huevos, lo que representa un 4,46%, una cifra demasiado alta, más aún sabiendo que el valor menor del rango es más alto que cualquiera de los otros 3 valores de sus competidoras, como veremos a continuación.
Se escogerán siempre valores dentro del rango para representarlos dentro de las tablas.
Los datos para las dos partes del artículo se extrajeron directamente de las páginas web de cada casa de genética, entre el 12 de marzo y el 20 de mayo de 2025.
*Valor estimado
Tabla 1.1. Huevos por ave alojada acumulados
La tabla confirma que las cuatro estirpes semipesadas presentan una curva de puesta acumulada muy parecidas desde las 60 hasta las 100 semanas, siendo casi idénticas las de Isa Brown y Hy-Line Brown.
Las diferencias, inferiores al 0.9 %, son matemáticamente marginales, pero todos sabemos que para un lote puede suponer una diferencia de 300.000 huevos.






Volo USA es el equipo perfecto para quienes buscan versatilidad y eficiencia. Un sistema “convertible” capaz de responder a las distintas necesidades de la producción moderna: puede configurarse tanto como colonia enriquecida como en versión aviario.
Disponible en diferentes anchos (186, 223 y 233), Volo USA se ofrece en versiones de 2 y 3 niveles, con la opción de pasillos transitables intermedios, facilitando así el manejo y el control de los animales.
ADAPTABILIDAD, VERSATILIDAD, BIENESTAR: el equilibrio perfecto entre innovación tecnológica y sencillez de gestión en un sistema único e integrado Agente Valli España
Valli Italy - Forlì +39 0543 975311
info@valli-italy.com www.valli-italy.com

#Persistencia = (tasa a las 100 sem / tasa en Pico) × 100.
*Valor estimado
Cómo en la Tabla 1.1 de huevos por ave, el porcentaje de puesta presenta estabilidad en la caída de producción de los lotes, es decir, producciones predecibles.
Sin embargo, la persistencia calculada del pico a la semana 100, marca que las gallinas Hy-Line Brown tienen un mejor descenso. La progresión lineal indica un desempeño estable y predecible para todas las líneas genéticas.

*Valor estimado
1. 3. Peso Huevo ave alojada acumulado (g)

Es curioso que de los 9 valores que aparecen en la hoja de la guía de manejo donde se han extraído los datos de las Hy-Line Brown, 7 de ellos están dados en un rango amplio, menos la mortalidad y la masa de huevo ave-alojada Tabla 1.4.
*Valor estimado
Como se ha dicho al inicio, no se va a decir aquí, que gallina es la mejor y mucho menos cual es la menos buena, pero si dejamos al alcance del productor otra herramienta más de trabajo para la elección.
Estas tablas permiten discernir matices en comportamiento productivo sin desmerecer ninguna estirpe, facilitando decisiones según prioridades de cantidad, peso o persistencia.
Es importante saber que, para calcular los valores de peso de huevo por ave alojada (Tabla 1.3) se ha hecho con los valores de masa de huevo de la Tabla 1.4. (fijos) y los de la Tabla 1.1 (en rango).
Esto quiere decir que los valores escogidos, a pesar de estar en la parte baja del rango, son bastante realistas, teniendo en cuenta otros datos que se dan en las guías.
Tabla 1. 4. Masa de huevo acumulada por ave alojada (kg)
En el siguiente número de la revista, continuaremos con el análisis de las estirpes ligeras.
Además, terminaremos con una comparativa simple de la nutrición requerida y su coste para gallinas Semis y Ligeras.
Comparativa principales estirpes Semipesadas de puesta DESCÁRGALO EN PDF


Su estructura intuitiva permite que las ponedoras se adapten fácilmente desde el primer momento.

Su diseño abierto permite una inspección visual rápida y directa de las aves, huevos y nidales.
mayor capacidad, y todo el sistema ha sido diseñado para una instalación sencilla y un mantenimiento sin complicaciones. Eficiencia y practicidad en un solo aviario.



La empresa líder en servicios de carga y descarga de aves refuerza su posición en el sector con unas instalaciones de 2.400 m² y una previsión de facturación superior a los 14 millones de euros.
El pasado 28 de mayo, la empresa Serproavi, referente nacional en servicios logísticos avícolas, dio un importante paso adelante con la inauguración oficial de su nueva sede central en Puente Genil (Córdoba).
El acto, celebrado al mediodía en la calle Cuesta del Molino, congregó a numerosas personalidades del ámbito político, empresarial e industrial de la comarca, consolidando la relevancia que la compañía ha alcanzado en el sector agroalimentario


nuevo edificio corporativo responde a las crecientes necesidades operativas de Serproavi, que ha vivido en los últimos años una expansión sostenida.

Actualmente, la firma roza una cuota del 50% en el mercado nacional de carga y descarga de aves, con una plantilla cercana a los 500 trabajadores distribuidos por todo el territorio español y un a facturación prevista que supera los 14 millones de euros en este ejercicio.


Posteriormente, tomó la palabra Antonio Caballero, consejero delegado de Serproavi, quien explicó los motivos que llevaron a la empresa a fijar su centro de operaciones en esta localidad cordobesa:

“Hemos elegido Puente Genil por ser una ciudad dinámica, con proyección de futuro y una ubicación privilegiada en el corazón de Andalucía. Ha sido un proceso complejo, pero estamos satisfechos con los resultados. Hoy abrimos una nueva etapa con ilusión y compromiso”, afirmó Caballero.
Uno de los momentos más emotivos del acto lo protagonizó Mª Ángeles Payán, en representación de los clientes de Serproavi, quien destacó la transformación del oficio de carga y descarga de aves en una actividad profesionalizada y con estándares de calidad elevados:

“Aquí hay empresarios que no solo crean empresas, sino que lo hacen muy bien. La labor de Serproavi ha contribuido decisivamente a dignificar este trabajo y a mejorar la eficiencia de toda la cadena avícola”, subrayó.


Por parte de la administración local, el alcalde de Puente Genil, Sergio Velasco, celebró la apuesta de Serproavi por el municipio:
“Es una fortuna que haya empresarios que elijan invertir en Puente Genil. Nuestra ubicación estratégica en el centro de Andalucía ofrece enormes ventajas logísticas. Estoy seguro de que esta alianza entre empresa y territorio generará grandes oportunidades”, señaló Velasco, quien también animó a la firma a participar activamente en las iniciativas formativas locales para fomentar el empleo y el desarrollo socioeconómico.

La clave del éxito de Serproavi reside en la combinación de tres pilares fundamentales:
La profesionalización de su equipo humano.
La apuesta decidida por la innovación tecnológica.
El estricto cumplimiento de los más altos estándares en bioseguridad y bienestar animal.

El acto concluyó con la intervención del CEO de Serproavi, José Manuel Linares, quien quiso agradecer públicamente el apoyo recibido tanto por parte de las instituciones como del tejido empresarial comarcal:
“Es un honor contar con vuestro respaldo. Ojalá sigamos creciendo juntos. Esta sede no es solo un edificio: es un símbolo de nuestro compromiso con el sector y con nuestra tierra”, expresó.
En un sector tradicionalmente invisible, la compañía ha sabido visibilizar y elevar la importancia de una labor imprescindible para garantizar la eficiencia y la seguridad de la producción avícola.
Serproavi inaugura su nueva sede central en Puente Genil con ambiciosos planes de crecimiento DESCÁRGALO EN PDF
Con esta nueva sede y una visión de futuro ambiciosa, Serproavi se consolida como un actor clave en la modernización del sector avícola españo l, marcando el camino hacia una logística más eficiente, segura y responsable.

Eduardo Cervantes López Consultoría Internacional - Gerencia Productiva e Innovadora en Procesamiento de Aves

¡El mundo moderno plantea dos grandes desafíos para el negocio del pollo de engorde!
No para de crecer. Ya somos 8 mil millones.
El consumo de carne de pollo aumenta sosteniblemente.
Dentro de este crecimiento gradual hay varios grupos humanos que padecen hambre y/o están desnutridos, debido a la dificultad para mejorar la calidad de los alimentos que consumen: Niños, ancianos, desempleados completamente y otros de forma parcial, refugiados legales e ilegales, indigentes, indígenas, etc.

En este punto me pregunto:
¿Por qué los dirigentes de estas asociaciones avícolas han sido discretos con el propósito de divulgar todos los beneficios nutricionales comprobados científicamente que tiene la carne de pollo?
Muchos de ellos esporádicamente pueden llegar a consumir y disfrutar la carne de pollo.
Esta realidad cotidiana plantea un gran reto social:
¿Es posible direccionar el costo de una parte de su proceso y ofrecerlo a algunas comunidades desprotegidas?
¡Afortunadamente el pollo sigue consumiéndose gracias a no existir campañas sistemáticas para dar a conocer todos los beneficios nutricionales que tiene esta milagrosa carne!
Contiene el mayor porcentaje de proteína – 21% - de origen animal terrestre.
Además, vitaminas, minerales que contribuyen de manera efectiva a mantenernos nutridos y saludables.
En Google se encuentran los beneficios detallados en los distintos órganos y sistemas que conforman el ser humano.

Un mega producto demanda efectuar dos gestiones permanentes:
Ajustar todos los Decomisos y Desperdicios a los parámetros gerenciales, ampliamente divulgados en artículos publicados en físico y digitalmente a través de los distintos medios.
Planificar el aumento de la producción de pollos mensual, teniendo presente crear una infraestructura y los sistemas de operación apropiados a fin de que las Pérdidas de Productos Vendibles (PPV), estén dentro de parámetros de gestión.

Verificación del cumplimiento y/o disminución de los parámetros de control establecidos en las etapas de prefaena.
Las naves pueden estar divididas en varios grupos de aves, equivalentes a las cantidades de animales a capturar, enjaular y subir los contenedores a los camiones.
Cuando las naves no tienen cerramientos, las cuadrillas de recolección deben construirlos. Para tal efecto, los cargadores deben seguir disciplinadamente el procedimiento establecido por las compañías. Se citan algunos:
Ingreso a las naves
El personal de captura debe caminar despacio y en silencio, con el propósito de no ocasionar estrés a los pollos.
El grupo de cargadores debe lograr que los animales se comiencen a mover tranquilamente hasta el sitio donde se encuentran los trabajadores que realizarán el atrape y enjaulado.
Logros: Disminuir significativamente los arañazos, hemorragias, hematomas, dislocaciones en los muslos y/o alas, etc.
Estos sufrimientos van en dirección opuesta a los lineamientos establecidos por el área de Bienestar Animal.
Manipulación de la distribución con jaulas llenas y su adecuada organización en los camiones
Son determinantes para impedir que las aves sufran afectaciones en su integridad física.
Propósito: Una vez llegan a la plataforma debe completarse la altura de los contenedores y transportarlos usando carritos con un diseño especial que tienen un doble beneficio:
En los pollos se reduce el estrés ocasionado al interrumpir la tranquilidad que debe caracterizar esta nueva condición: Enjaulado.
El personal disminuye la curva de fatiga, manteniéndose un rendimiento estable.
Salvo algunas excepciones los conductores de los camiones tradicionalmente han sido espectadores pasivos. Aprovechan este momento crítico de la subida y organización de la carga para dormir.
Este detalle da la impresión de no tener ninguna responsabilidad en cuanto a la calidad física de esta frágil carga que transportan y total desconocimiento de la exactitud en la cantidad de pollos que movilizan. Se limitan a recibir de parte de la granja la remisión que entrega en la planta.
Poner en práctica esa filosofía dual donde se conserva un ambiente de comodidad para los protagonistas en la parte final de este negocio: Las aves y quienes las manejan.

Durante el transporte se debe estar monitoreando estos tres detalles:
Temperatura y humedad relativa en el interior de la carga donde se concentra la mayor cantidad de calor evaporativo. Cuando se sale de los parámetros establecidos, por ejemplo: climas calurosos: temperatura: 220C - 260C y HR: 65%, debe poner en operación los ventiladores ubicados detrás de la cabina. Propósito: reducir los pollos ahogados por estrés calóricos (DOA)
En la carretera, al tomar las curvas debe bajar la velocidad para disminuir los efectos de la fuerza centrífuga que desplaza los pollos lateralmente golpeándose las alas.
Al acercarse a los reductores de velocidad, el conductor del camión debe ir bajando de velocidad para pasar sobre ellos lentamente. De esta forma se disminuye la levitación de las aves donde se impacta la espalda con la parte superior de los contenedores.
Cuando caen se golpean las pechugas, ocasionándole hematomas en ambas partes: espalda y pechuga.
El monitoreo de los pollos muertos por estrés en climas calurosos reviste la mayor importancia, debido al impacto directo en el rendimiento en carne y los gastos de operación antes de llegar a la planta.
A los detalles mencionados anteriormente durante los cerramientos, captura, enjaulado de los pollos se deben supervisar el calor evaporativo a partir del instante cuando se inicia la organización de los contenedores con pollos. Para tal efecto, se debe acondicionar el entorno alrededor de los tráileres donde se están cargando, tales como:
Protección de la luz solar, uso de toldos móviles.
Baterías móviles de ventiladores con humificadores.
Mojar las aves a medida que se vayan organizando en la plataforma.
Acondicionamiento de la infraestructura que debe instalarse en el tráiler para crear una renovación del aire interior, ingresando por los pasillos a todo lo largo de la carrocería.
Propósito: conservar a las aves dentro de los parámetros de confort. 220C - 260C y Humedad relativa (HR) alrededor del 65%.
De igual manera, en la planta debe existir otras instalaciones diseñadas para que los animales estén tranquilos -carencia de estrés calóricos -, esperando su turno de proceso.

Si se cumplen disciplinadamente las sugerencias relacionadas anteriormente, es posible reducir el tradicional parámetro de gestión: 0,10% sobre el total de los pollos recibidos en la faenadora para el proceso mensual.
Algunas empresas en Latinoamérica están trabajando para disminuirlo y estabilizarlo en el 0,05%, ejemplo:
Proceso mes: 1.000.000 de pollos
Índice tradicional DOA: 0.10%
Total, aves/mes: 1.000 pollos
Nuevo índice (NDOA): 0,05% equivalente a solo 500 aves/mes
Aumento anual: 6.000 pollos.

Durante el faenamiento se producen una serie de situaciones que afectan la calidad.
Seguidamente se relacionan las más relevantes:
Colgado de aves en el transportador aéreo de sacrificio:
El ambiente de oscuridad requerido – luces azules, rojas o verdes- debe estar debidamente adecuado.
La renovación continua del aire para disipar el polvo y materia fecal seca que se genera durante la ubicación de las aves en los ganchos, utilizando ventiladores ruidosos afectará el bienestar tanto del personal como de los animales.
Este detalle afecta el rendimiento de los trabajadores y la relajación de los pollos.
La correcta instalación y graduación del masajeador de pechugas acorde con el tamaño de las aves que se están procesando, es un factor determinante para que lleguen debidamente tranquilas al aturdidor.
El acceso al aturdidor debe evitar que las aves padezcan Prechoque. Si ocurre se incrementará el aleteo intenso y muchos animales saldrán dañados de la tina del aturdidor.
Consecuencias: hemorragias, hematomas, dislocaciones en alas, etc.
El trayecto de la salida de la tina y la entrada a las guías de los sacrificadores automáticos y/o personal que corta los vasos sanguíneos debe demorarse de 10 a 12 segundos, cumpliendo las etapas tónicas y clónicas.
El sacrificio y desangre adecuado requiere que las variables eléctricas que rigen aturdimiento estén debidamente ajustadas, evitando la electrocución de los pollos y las rupturas de los huesos frágiles del tórax y los vasos sanguíneos que irrigan los músculos de esta parte del cuerpo. Así mismo, el tiempo de desangre debe considerar la temperatura ambiente y la altura sobre el nivel del mar.
Propósito: los pollos deben ingresar a la escaldadora completamente muertos, luego de evacuar entre el 45% y 50% de la sangre. El cumplimiento de este detalle puntual permite lograr el objetivo del rendimiento en seco de la carcasa.
El escaldado debe llevarse a cabo con la inmersión total de los pollos durante todo el trayecto, con una turbulencia del agua apropiada en la superficie de los tanques facilitando la dilatación de los folículos y el desprendimiento de las plumas debido a la desnaturalización de la proteína, condición sine qua non para lograr un desplumado productivo.
Este desplumado demanda que se cumpla siempre entre otras las siguientes condiciones:
Suministro permanente de agua tibia: 34ºC a 38ºC
Dedos colocados con la dureza acorde con la parte de los pollos que van a estar en contacto
Dedos completos y en buen estado.
La parte superior de las desplumadoras deben estar cubiertas para conservar el calor que existe durante el retiro de plumas.
Desplumadoras inclinadas secuencialmente hacia abajo a la salida para aumentar la eficiencia en la remoción de las plumas de las alas que están insertadas en el músculo al igual que las de la cola.
Revisión de los dedos al finalizar el turno diario para reemplazar los gastados, partidos y caídos. De esta manera, se garantiza un desgaste uniforme.
Recordar parámetro de consumo: 1 dedo por “mínimo” cada 20.000 pollos procesados.
Evisceración
Si los tiempos de ayuno y recolección de las aves establecidos se mantiene dentro de los parámetros establecidos y las afectaciones en la calidad de los pollos eviscerados:
Manchados por piel.
Contaminados por alimento
Perdidos durante el faenamiento
Adicionalmente, se ajustan a los índices de gestión, el acumulado de las pérdidas por los distintos conceptos deben estar dentro de estos datos de referencia o ser inferiores.
Esta información se actualiza como los conocidos Guinness Récords.
Ejemplo:
Proceso mensual: 1.000.000 pollos
Peso promedio vivo: 2.3 Kilos
Total, Kilos: 2.300.000 Kilos
Extrapolado a un año representan 49.680 Kilos extras
Para una empresa que faena 5 millones de pollos/mes, equivale a 248.400 kilos de carne adicionales.
A medida que se vayan alcanzando estas nuevas cantidades, los resultados de haberse creado una Cultura de Microgestión, los rendimientos irán subiendo y los costos de proceso por kilo comenzarán a disminuir, incrementando la competitividad en el mercado.
Esta soñada condición permitirá ofrecer productos de Calidad Grado A, a los segmentos más vulnerables de la sociedad, donde comer carne de pollo, significa lograr la gloria por alimentarse nutritivamente. Este sector especial de la economía seguirá aumentando el consumo, porque las empresas han definido un precio muy accesible a sus ingresos.
de Producto Vendible (PPV)
y traumatismos
ahogados (DOA)- Clima caluroso
Dañados en desplumadoras
Contaminación y pérdida de productos durante evisceración
Pérdida
El complemento de lo anteriormente analizado es determinar el momento en que las asociaciones avícolas y las compañías que las conforman decidan prudente pero irreversiblemente la hora de aumentar los encasetamientos en las diferentes etapas de este negocio.
Esta nueva fase debe ser gerenciada con las directrices de las empresas conscientes:

“¡Crecer amigablemente con el miedo ambiente y la humanidad que consumirá la mejor proteína animal del mundo!”
Desde el procesado del pollo de engorde: ¡Preparándonos para alimentar nutritivamente al mundo!
DESCÁRGALO EN PDF

Enterococcus cecorum es una bacteria que fue descrita por primera vez en el año 1983 bajo el nombre de Streptococcus cecorum como resultado de su aislamiento a partir de la flora intestinal de pollos sanos1 . Seis años después, se determinó mediante secuenciación que no mostraba relación con las especies del género Streptococcus y, por el contrario, se agrupaba con otros enterococos como Enterococcus faecalis, hecho que determinó el género y especie por el que lo conocemos hoy en día 2

En cuanto a su importancia patógena, no fue hasta el año 2002, tras su aislamiento en pollos de engorde con cojeras, cuando se publicaron los primeros informes que lo clasificaban como patógeno aviar 3,4
Hasta ese momento, tan solo se consideraba un comensal entérico beneficioso en las aves adultas por la producción de ácido láctico en el intestino.
En la actualidad, el incremento del número de reportes de cepas patógenas de Enterococcus cecorum ha situado a este agente en el punto de mira de la industria avícola, siendo responsable de importantes pérdidas económicas como consecuencia del incremento de mortalidad, costes de tratamientos y decomisos en mataderos 5,6 .

Estudios comparativos entre cepas patógenas y no patógenas de E. cecorum, destacan que las cepas patógenas están adaptadas para colonizar el intestino en etapas tempranas de la vida del animal, a diferencia de las no patógenas que no se detectan antes de la tercera semana de vida.
Esto supone una ventaja competitiva potenciando su diseminación durante toda la producción.
Además, los aislamientos en animales sanos tienen mayor diversidad que aquellos procedentes de animales con clínica, lo cual sugiere una evolución de clones específicos con mayor potencial patógeno7.

Hoy en día, todavía no se conoce con exactitud la patogenia de este agente, aunque las últimas investigaciones apuntan a que se produce una diseminación de la bacteria desde el ciego hacia el torrente sanguíneo favoreciendo su propagación sistémica hacia las microfisuras de los huesos en las placas de crecimiento.
Estas microfisuras, conocidas como osteocondrosis disecante, son el resultado de múltiples causas como estrés mecánico, desarrollo anómalo del cartílago, factores genéticos, nutricionales…
Una vez E. cecorum coloniza estas regiones, bastante inaccesibles a los antibióticos y al sistema inmunológico del huésped, induce necrosis⁸.
En ocasiones, también puede llegar a invadir otras localizaciones como el pericardio, pulmón, hígado y bazo produciendo lesiones en ellas 9
Algunas investigaciones señalan el estrés térmico como posible factor predisponente debido a que aumenta la permeabilidad intestinal, favoreciendo la salida de ciertas bacterias como E. cecorum y, con ello, la aparición de bacteriemia10.
La vía de transmisión del agente es horizontal por contacto directo o indirecto entre animales sanos y enfermos, considerándose la vía oral durante el primer día de vida tras la eclosión la más probable12 .
No obstante, no se puede descartar por completo la transmisión vertical puesto que requiere de más estudios para comprender el alcance y condiciones bajo las cuales podría ocurrir13 .
Sin embargo, el desarrollo de la infección es multifactorial y también puede depender de otra serie de factores como:
La genética del hospedador
El rápido crecimiento
La composición del alimento
El manejo y densidad de la granja
El potencial patógeno de la bacteria11
El diagnóstico de E. cecorum debe ser considerado como un proceso integral que combine tanto el diagnóstico clínico presuntivo, realizado por el veterinario en la explotación, como el diagnóstico laboratorial, que permita confirmar la presencia del patógeno mediante pruebas específicas.

Las infecciones producidas por E. cecorum pueden ocasionar una fase septicémica aguda que se caracteriza por la ausencia de signos clínicos y un aumento de la mortalidad en torno al 5-10% alrededor del día 14 de vida.
Las aves que sobreviven a esta etapa frecuentemente desarrollan infecciones crónicas, donde comienzan a ser aparentes los signos clínicos14
Aquellos signos que pueden alertar al veterinario de la presencia de cepas patógenas de E. cecorum son la cojera y la parálisis de las extremidades traseras, que hace que los animales adopten una postura denominada “pollo motorista”.
A nivel postmortem, lo más frecuente es la formación de abscesos en la vértebra torácica libre, lesión conocida como espondilitis o kinky back (Imagen 1), aunque también pueden producirse otras anomalías tales como pericarditis o esplenomegalia15 .
Para llevar a cabo un diagnóstico laboratorial adecuado, es imprescindible realizar un correcto muestreo en la explotación.
La elección de las muestras varía en función de los signos observados:
Si los animales presentan cojera , se deben tomar muestras articulares mediante hisopos con medio de transporte, o en su defecto, enviar las articulaciones afectadas.
Si se observan abscesos en la vértebra torácica, se tomarán muestras de esta área o se enviará la vértebra completa.
En ambos casos, las muestras deben tomarse de la forma más aséptica posible, para evitar la contaminación con otros agentes, y enviar al laboratorio en refrigeración para preservar la viabilidad bacteriana.
Los animales mayoritariamente afectados son los pollos de engorde y las reproductoras, sin embargo, otras especies aviares como pavos, palomas y patos Pekín también pueden ser susceptibles en menor medida16

Imagen 1. Formación de absceso en la vértebra torácica libre. Fuente: imagen cedida por Alicia Uixera, Granja Pinseque S.A
El cultivo microbiológico resulta fundamental, ya que los signos clínicos y las lesiones macroscópicas pueden solaparse con otros agentes bacterianos causantes de problemas articulares como otros enterococcos, Escherichia coli o Staphylococcus aureus 14
Para ello, se procederá al cultivo bacteriano de las muestras en medios agar donde el crecimiento de E. cecorum (Imagen 2) se observará en forma pequeñas colonias de 1-2 mm, con forma redondeada, color gris blanquecino y alfa hemólisis, tras un periodo de incubación a 37ºC de 24-48 horas17
Esta bacteria se clasifica como Gram positiva, anaerobia facultativa y catalasa negativa.
Posteriormente, para confirmar su identificación de forma precisa y objetiva se debe proceder a su lectura mediante la herramienta de espectrometría de masas MALDI-TOF.
El estudio de sensibilidad antibiótica cobra una especial importancia para este agente debido a la elevada resistencia a los antimicrobianos que presenta, siendo clasificada como una de las bacterias resistentes más relevantes en la Unión Europea
Una vez confirmado el aislamiento de E. cecorum, el laboratorio puede evaluar la sensibilidad antibiótica mediante la realización de antibiogramas por el método de Kirby Bauer o halos de inhibición o bien utilizando la técnica de concentración mínima inhibitoria (CMI), con el fin de proporcionar al veterinario clínico una herramienta que le facilite la selección del antibiótico más adecuado.


La PCR a tiempo real, qPCR , confirma de forma rápida y precisa la presencia o ausencia de E. cecorum en base a la detección de secuencias específicas de ADN, además de cuantificar la cantidad de material genético presente en la muestra.
Por otro lado, su alta sensibilidad la hace idónea para realizar monitorizaciones ambientales, analizando la presencia de esta bacteria en muestras de suelo, puertas, bebederos, polvo y aire de granjas de pollos de engorde13
De igual modo, resulta útil para estudiar los posibles factores de virulencia (FV) asociados a las cepas patógenas de E. cecorum.
Sin embargo, se requieren más investigaciones que determinen , ya que en la actualidad todavía no hay
En 2017, Jung y colaboradores, estudiaron los siguientes FV; gelE, esp, asa1, ccf, hyl y efaAfs, mientras que en 2023 Huang y colaboradores utilizaron una batería mucho más amplia, conformada por 18 factores de virulencia.
Por último, esta técnica permite ampliar el diagnóstico diferencial con otros agentes causantes de cojeras de origen vírico, como el Reovirus, y bacterianos, como Mycoplasma synoviae.
Igualmente, es capaz de identificar la presencia de otros enterococos implicados en procesos articulares como E. hirae, E. faecalis y E. faecium, así como otras bacterias ya mencionadas anteriormente


La histopatología permite identificar las lesiones específicas causadas por E. cecorum, así como la extensión, localización de la infección y presencia de otros agentes de forma concomitante.
A nivel histológico, en aquellos animales con espondilitis, se observan microfisuras cartilaginosas de tamaño variable a menudo rellenas de trombocitos, fibrina y eritrocitos de forma parcial o completa en las primeras semanas de infección.
En cuadros más crónicos, las microfisuras se observan dominadas por heterófilos y macrófagos, acompañadas de remodelación ósea y compresión de la médula espinal subyacente21 .
El tratamiento antibiótico se debe aplicar en las fases más tempranas de la enfermedad, ya que su administración en las aves paralizadas, con procesos más crónicos, resulta ineficaz debido a la dificultad del propio antibiótico, y del sistema inmune del hospedador, para llegar a las zonas articulares donde se acantona la bacteria 8
Para el control de E. cecorum, implementar un exhaustivo plan de bioseguridad y llevar a cabo un correcto manejo de los animales es crucial.
Algunas medidas a considerar son efectuar una correcta limpieza y desinfección de las naves, controlar la temperatura y ventilación y realizar controles del agua que descarten la presencia de este agente.
Por otro lado, cabe mencionar la posibilidad de diseñar y aplicar autovacunas específicas para cada unidad epidemiológica, puesto que en la actualidad no se dispone de vacunas comerciales.
Enteroccocus cecorum es un agente reemergente, causante de importantes pérdidas económicas, que no debe ser infravalorado.
El diagnóstico clínico presuntivo siempre debe respaldarse en un diagnóstico laboratorial.
Realizar un diagnóstico diferencial con otros agentes víricos y bacterianos causantes de cojeras, resulta fundamental.
La microbiología convencional y las técnicas de qPCR son las herramientas laboratoriales de elección para el diagnóstico de esta patología.
Antes de usar antibióticos es preciso realizar estudios de sensibilidad antibiótica.
Su control viene condicionado por su carácter multifactorial y no solo infeccioso.

¡Casque el futuro de los avances en avicultura, huevos, piensos y carne! Desde tecnología innovadora hasta redes globales, IPPE es el lugar donde las ideas eclosionan y usted puede descubrir miles de innovaciones para su negocio, dirigidas a la salud avícola, alojamiento, logística, empaques y mucho más. ¡No pierda la oportunidad de que el éxito eclosione en su negocio!
27-29 de enero de 2026. ATLANTA, GA, EE. UU.
HAZ TUS PLANES Y ÚNETE A NOSOTROS.
ASEGÚRATE DE INSCRIBIRTE EN IPPEXPO.ORG
Eliana Icochea D’Arrigo Laboratorio de Patología Aviar Facultad de Medicina Veterinaria, UNMSM-Lima-Perú
La enfermedad de Newcastle (ENC o ND) es considerada una de las enfermedades infecciosas más importantes de las aves, porque las cepas velogénicas del virus pueden causar brotes con alta morbilidad, mortalidad y restricción del comercio internacional.
Lo cual, ocasiona importantes pérdidas económicas a la industria avícola, por ello, la enfermedad forma parte de la lista de enfermedades notificables a la Organización Mundial de Salud Animal (Miller y Koch, 2020).
La enfermedad de Newcastle se previene con bioseguridad y vacunación, y aun cuando varios tipos de vacunas efectivas, vivas e inactivadas son aplicadas, la ENC continúa siendo un problema en muchos países del mundo.


La base de datos del comité internacional de taxonomía viral clasifica al virus como familia Paramyxoviridae, subfamilia Avulavirinae, esta última distribuida en tres géneros:
Orthoavulavirus.
Metaavulavirus.
Paravulavirus.
Los paramixovirus aviares han sido aislados de diferentes especies de aves, y son clasificados en 21 serotipos por pruebas serológicas y análisis filogenético (WOAH, 2021).
La enfermedad de Newcastle es causada por cepas virulentas de Paramixovirus aviar tipo 1 (APMV-1), especie
El virus de la enfermedad de Newcastle (VEN), tiene un genoma de ARN de cadena simple, no segmentado, de sentido negativo, que mide 15.186 nucleótidos (Alexander, 2003).
El virión presenta una envoltura cubierta con dos capas lipídicas derivada de la membrana plasmática de la célula hospedera (Mast y Demeestere, 2009).
El genoma del virus está compuesto por seis genes en orden 3´-NP-P-M-FHN-L-5´, que codifican siete proteínas virales:
Nucleoproteína (NP), Fosfoproteína (P),
Proteína de la matriz (M),



La edición del ARN de la proteína P produce una proteína adicional, la proteína V, con actividad anti-interferón, que permite al virus contrarrestar la respuesta innata de la célula huésped (Miller y Koch, 2020) (Figura 1).
ORTHOAVULAVIRUS AVIAR 1
Complejo RNP
Ribonucleoproteina
Proteina asociadas a la membrana
P, L ARN viral
Figura 1. Representación esquemática del genoma del virus de la ENC y sus proteínas.
La principal propiedad biológica del virus es aglutinar glóbulos rojos de aves, anfibios y reptiles, esto debido a la acción de la proteína HN sobre los receptores de ácido siálico de la superficie de los glóbulos rojos.
Desde hace algún tiempo viene siendo investigado el efecto oncolítico de algunas cepas del VEN sobre las células tumorales humanas y su uso como tratamiento contra el cáncer en humanos.
Este efecto está asociado a la actividad anti-interferón tipo I de la proteína V.
La hemoaglutinación (HA) viral permite determinar la presencia viral en cultivos virales y fluido alantoideo de embriones de pollo (Miller y Koch, 2020), y cuantificar los anticuerpos en el suero de las aves mediante la prueba de inhibición de la hemoaglutinación (IHA).
La selectiva replicación que tiene el virus en células tumorales se debe a defectos de estas en la activación de las vías de señalización del IFN tipo I y en las vías apoptóticas entre otras (Schirrmacher, 2017).


Después de la entrada de la nucleocapside viral al citoplasma, esta se disocia de la proteína M y se libera para iniciar la síntesis del ARNm requerido para la traducción de las proteínas virales. La proteína P media la unión del complejo de polimerasa a la nucleocapside y la proteína L realiza las actividades catalíticas de la polimerasa (Dortmans et al., 2011; Cox y Plemper, 2017).

La proteína M de la matriz, organiza el ensamblaje de las partículas virales a través de la interacción con las proteínas N del complejo RNP y los complejos glicoproteicos integrados a la membrana (Cox y Plemper, 2017).
Las nuevas partículas virales salen por gemación brotando de la super cie celular, arrastrando la envoltura lipoproteica de la célula (Miller y Koch, 2020; Cox y Plemper, 2017).
La neuraminidasa de la proteína HN permite liberar al virus de la célula, removiendo el receptor celular (Bergfeld, 2017).

que Cepas velogénicas viscerotrópicas
(ambas causantes de la enfermedad apatógenas (usadas como vacunas).

Un índice de patogenicidad intracraneana (IPIC) igual o mayor a 0,7 (teniendo en consideración los valores mínimos y máximos de 0 a 2) o,
El sitio de escisión de la proteína F es de múltiples aminoácidos básicos y tiene una
La glicoproteína F es la clave de virulencia y patogénesis viral, debido a que el ingreso a la célula depende de la fusión de la membrana celular y viral, después de la escisión de la proteína F0 en F1 y F2, por las proteasas del huésped (Miller y Koch, 2020).
La diferencia entre un virus virulento y uno no virulento es que:
Los virus con una secuencia de aminoácidos monobásica en el sitio de escisión de F0 son apatógenos porque:
Este substrato es susceptible solo a enzimas excretadas en mucosas, como tripsina, por lo tanto, ocasionan una infección localizada.

Contrariamente los virus con una secuencia dibásica son patógenos porque son:
Susceptibles de enzimas intracelulares ubicuas, que permiten al virus diseminarse y causar una infección sistémica y mortal (Czeglédi et al., 2006; Miller y Koch, 2020).
El índice de patogenicidad intracraneana (IPIC), es el mejor método para determinar patogenicidad viral determina la patogenicidad de las cepas, sino que cuantifica en valores.
El uido alantoideo con rmado positivo por HA con un título hemaglutinante mayor a 1:16 es diluido 1/10 en solución salina e inyectado intracranealmente a una dosis de 0,05 mL a diez pollos SPF de 1 día de edad.
Las aves son examinadas diariamente durante 8 días, asignándoles un score diario de: 0 si normales, 1 si enfermas y 2 si mueren.
Se considera que un virus es patógeno cuando tiene un IPIC igual o mayor a 0,7 (WOAH, 2021). Existen grandes diferencias en patogenicidad entre cepas del virus. El Cuadro 1, resume el índice de patogenicidad de los diferentes patotipos usando diferentes pruebas (Alexander, 1989 y 1998).
registradas como 2 en cada uno de los días siguientes hasta los 8 días.
El IPIC se calcula con el promedio de score diario por ave durante los ocho días; los virus más virulentos se acercan al score máximo de 2,0 y los virus lentogénicos a 0,0.


Patotipo
Rangos de índices Ejemplos de virus
Viserotrópico velogénico <60 1.5-2.0 2.0-3.0
Neurotrópico velogénico
Hertz ’33, Milano
1.5-2.0 2.0-3.0 Texas GB
Mesogénico 60-90 1-1.5 0.0-0.5
Se considera que todos los aislamientos de APMV-1 pertenecen a un solo serotipo, sin embargo, algunas variaciones antigénicas han sido demostradas entre diferentes aislamientos mediante diversas pruebas y, aun cuando no existen variaciones antigénicas entre cepas, el análisis genético se ha convertido en el principal método de caracterización y ha reemplazado al uso de mAbs para tipificar los aislamientos de los VEN.
Lentogénico >90 0.2-0.5 0.0
Asintomático
Roakin, Komarov
Hitchner B1, La Sota,
Clone 30
Ulster 2C, V4, MC110
(Fuente: Alexander, 1998).

Los virus de ENC tienen bajas tasas de recombinación, sin embargo, a través del tiempo se han detectado ciertas diferencias antigénicas que han motivado la clasificación de las cepas dentro de linajes o genotipos. De acuerdo con esto las cepas son agrupadas en dos principales clases, virus de clase I y virus de clase II;


Los virus de clase I son de baja patogenicidad y son encontrados en aves silvestres.
Mientras que los de clase II, están clasificados en múltiples genotipos y pueden ser no patógenos o virulentos (Cuadro 2).
La caracterización del genotipo del VEN, se logra secuenciando el gen F completo, lo que además permite determinar su virulencia;
Para identificar nuevos genotipos es usado un sistema basado en una distancia evolutiva media de 10% entre grupos genéticos (Dimitrov KM et al 2016; Dimitrov KM et al, 2019).
2. Clasificación de genotipos del virus
Virulencia
I Silvestres Baja (exc Irlanda 90)
Genotipo Tipo ave
Virulencia
I Silvestres Baja (exc Aus 98) PHLYMV42
II B1, La Sota, VG-GA
III-IX Virulentas
X Silvestres domésticas Baja
XI-XXI Virulentas
El desarrollo de secuenciación de próxima generación, en inglés Nextgeneration sequencing (NGS), ha surgido como herramienta para investigación y caracterización genética de patógenos.
Sin embargo, este método es ideal para los virus RNA que mutan rápidamente, donde se requiere además analizar aspectos evolutivos (Butt et al., 2019).

La clasificación actual de genotipos incluye tres nuevos genotipos (XIX, XX y XXI), haciendo un total de 21 genotipos virales dentro de los virus de clase II (Dimitrov et al. (2019).

Por ser un virus con envoltura, la viabilidad de los Paramixovirus aviares es destruida fácilmente por agentes físicos y químicos tales como:
Calor,
Luz ultravioleta,
Procesos de oxidación, pH y
Tratamiento con la mayoría de los desinfectantes.
No obstante, las publicaciones referentes a tiempos de supervivencia del virus fuera del huésped muestran diferencias atribuidas a temperatura, humedad ambiental y el medio en el cual el virus fue analizado (Kinde et al., 2004).
Enfermedad de Newcastle: Conociendo mejor al virus para tomar las mejores decisiones en el control. Parte I DESCÁRGALO EN PDF


· Eficacia probada por normas UNE oficiales europeas.
· 100% Estable.
· 100% Biodegradable.